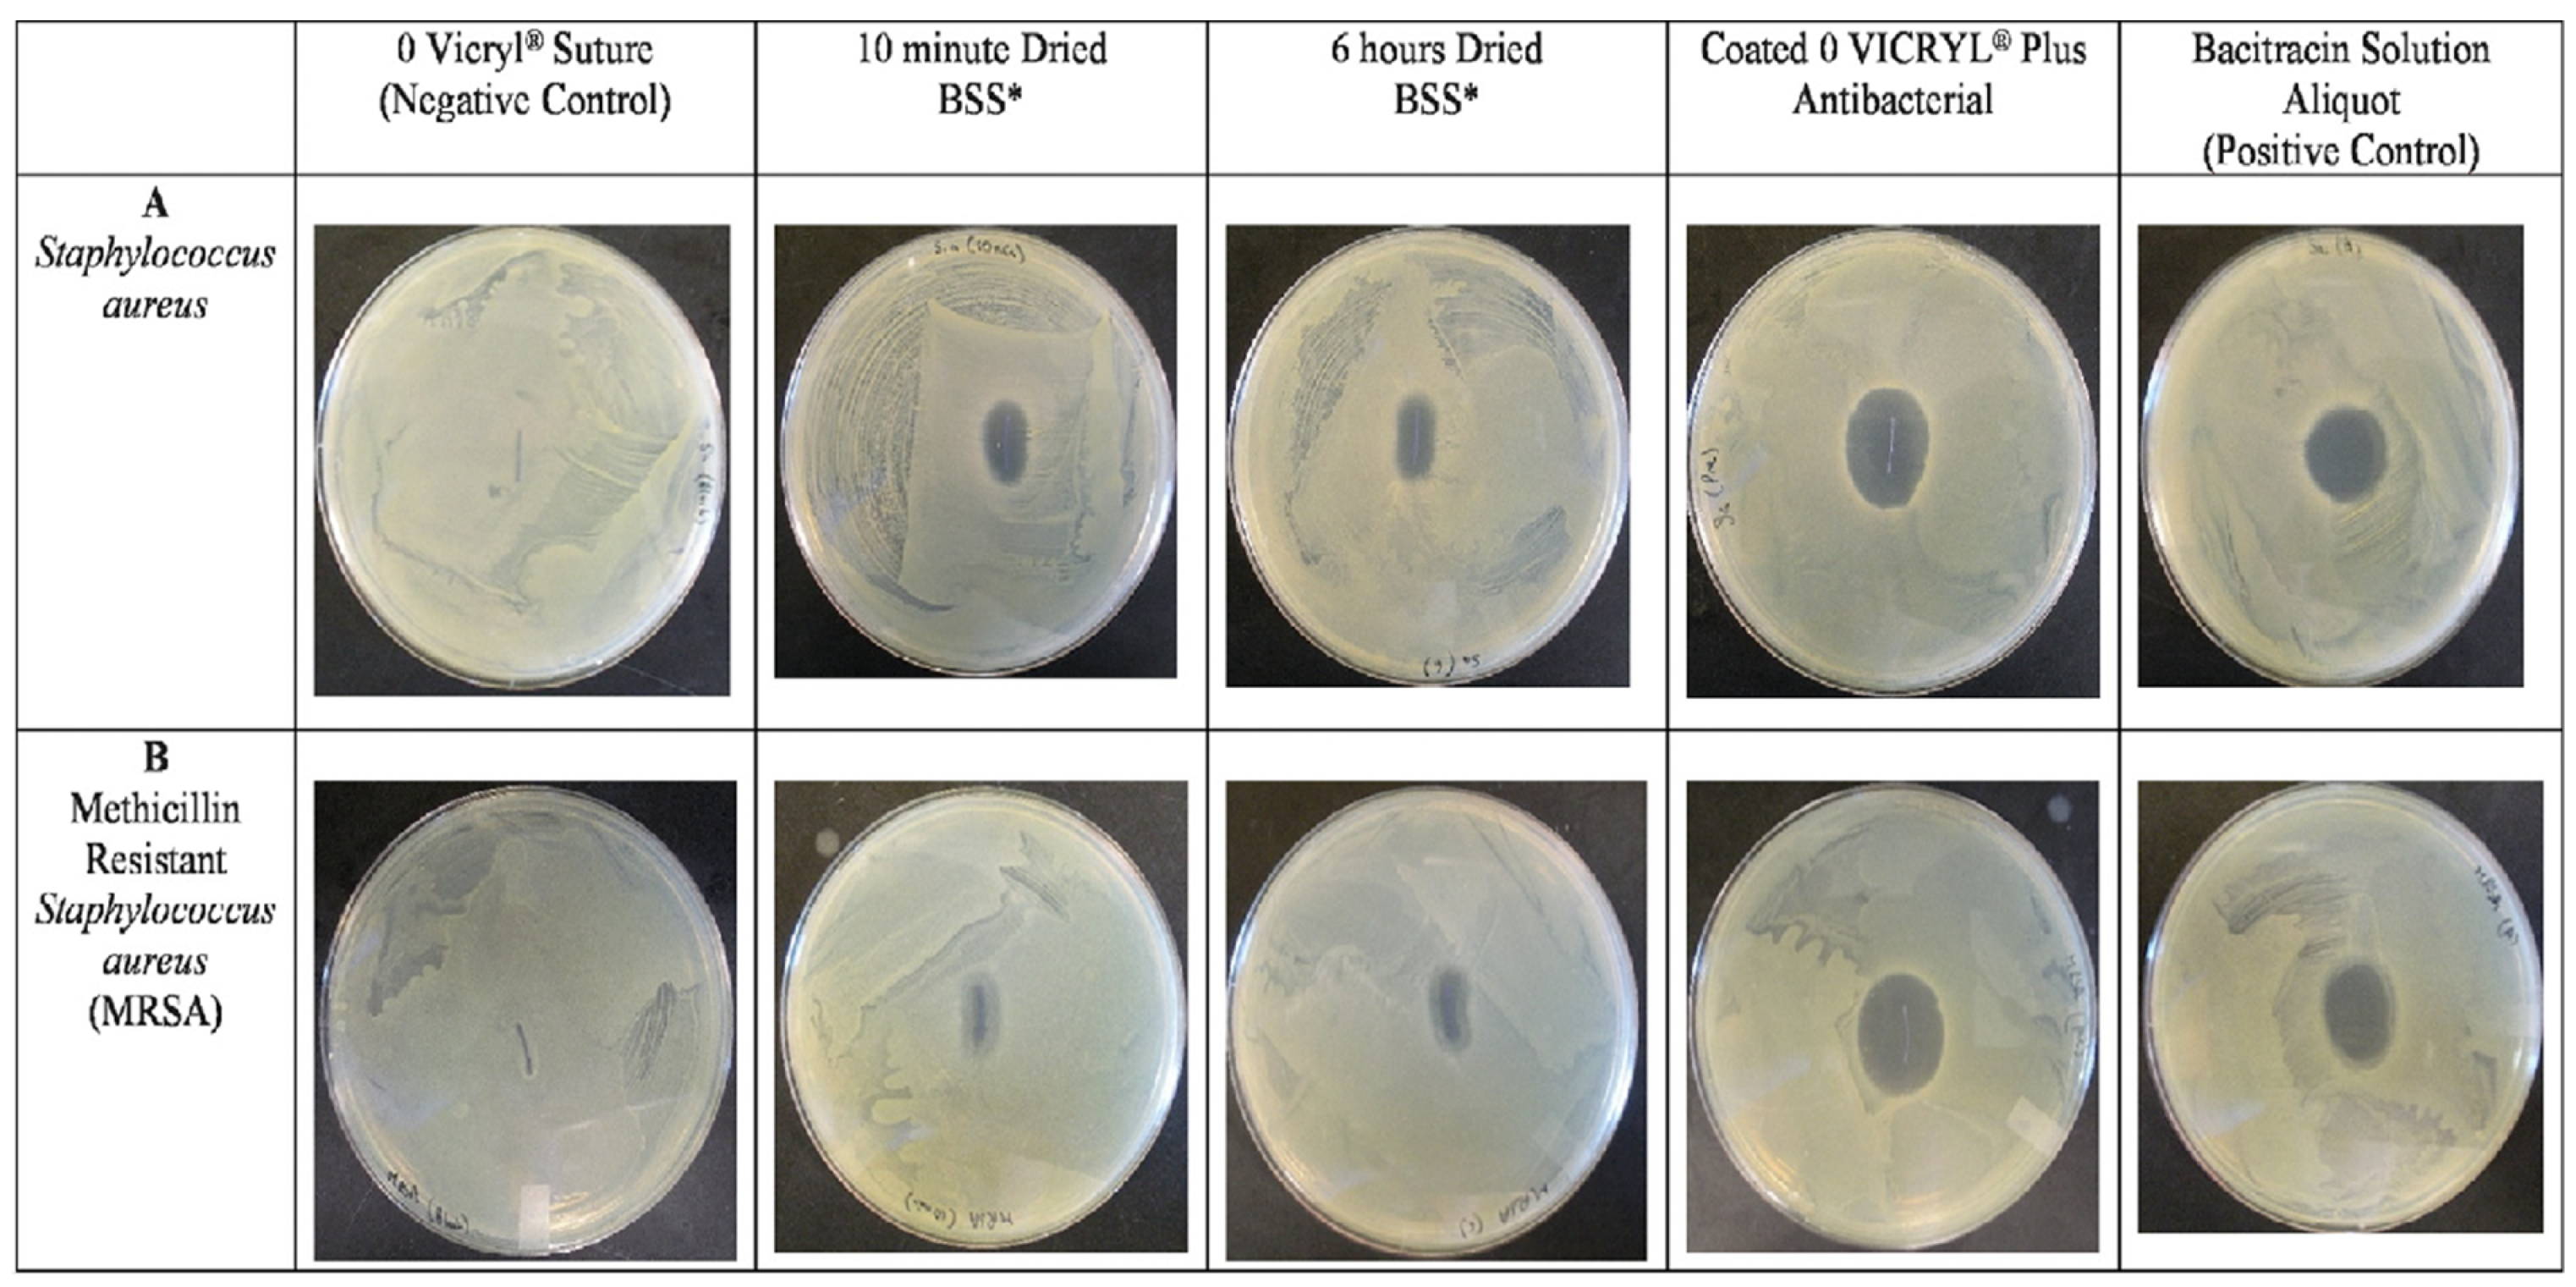
Applmicrobiol 03 00044 g012

Biofilm Formation, and Related Impacts on Healthcare, Food Processing and Packaging, Industrial Manufacturing, Marine Industries, and Sanitation–A Review
Abstract
:1. Introduction
2. Microbial Contamination, Biofilm Formation, and Healthcare-Related Impacts
2.1. The Role of Material Surface on the Formation of Conditioning Films and Biofilms
2.2. Biofilm Formation Steps and Its Characteristics



3. Biofilm Formation Challenges to Healthcare, Water Distribution Systems, Food Processing and Packaging, and Marine Industries
3.1. Healthcare
3.2. Water Distribution Systems
3.3. Food Processing and Packaging
3.4. Industrial Manufacturing
3.5. Marine Industries
3.6. Sanitation
3.7. Biofilm in Microbiologically Influenced Corrosion (MIC) of Metallic Alloys in the Oil and Gas Industry
4. Recent Trends in Antimicrobial Material Research, Infection Control and Prevention
4.1. Strategies to Design Anti-Biofilm or Antifouling Surfaces and Materials
4.2. Designing Protein-Repellent, Cell-Repellent, and Self-Cleaning Surfaces
4.2.1. Mimicking the Surface Microtopography of Marine Organisms
4.2.2. Covering the Surface of Solids with Antifouling Polymers or the Chemical Immobilization of Anti-Foulant Groups
4.3. Designing Bactericidal Surfaces
4.3.1. Designing Bactericidal Surfaces through Modification of the Surfaces with Polymers with Inherent Antimicrobial Activity
4.3.2. Designing Bactericidal Surfaces through the Application of Antibacterial Agents
4.3.3. Application of Antibiotics in Designing Anti-Biofilm Surfaces
- Triclosan-coated VICRYL Plus sutures
4.3.4. Application of Nanoparticles in Designing Anti-Biofilm Surfaces
4.3.5. Designing Anti-Biofilm Bulk Material
5. Nanoparticle–Bacteria Interactions
6. Future Directions
7. Conclusions
Author Contributions
Funding
Data Availability Statement
Conflicts of Interest
References
- Nazir, R.; Zaffar, M.R.; Amin, I. Bacterial biofilms: The remarkable heterogeneous biological communities and nitrogen fixing microorganisms in lakes. Freshw. Microbiol. 2019, 307–340. [Google Scholar]
- Costa, O.Y.; Raaijmakers, J.M.; Kuramae, E.E. Microbial extracellular polymeric substances: Ecological function and impact on soil aggregation. Front. Microbiol. 2018, 9, 1636. [Google Scholar] [CrossRef] [PubMed] [Green Version]
- Chen, M.; Yu, Q.; Sun, H. Novel strategies for the prevention and treatment of biofilm related infections. Int. J. Mol. Sci. 2013, 14, 18488–18501. [Google Scholar] [CrossRef] [PubMed] [Green Version]
- Khatoon, Z.; McTiernan, C.D.; Suuronen, E.J.; Mah, T.-F.; Alarcon, E.I. Bacterial biofilm formation on implantable devices and approaches to its treatment and prevention. Heliyon 2018, 4, e01067. [Google Scholar] [CrossRef] [Green Version]
- Davies, D. Understanding biofilm resistance to antibacterial agents. Nat. Rev. Drug Discov. 2003, 2, 114–122. [Google Scholar] [CrossRef]
- Noguera, D.R.; Okabe, S.; Picioreanu, C. Biofilm modeling: Present status and future directions. Water Sci. Technol. 1999, 39, 273–278. [Google Scholar] [CrossRef]
- Swanson, T.; Wolcott, R.; Wallis, H.; Woodmansey, E. Understanding biofilm in practice: A global survey of health professionals. J. Wound Care 2017, 26, 426–440. [Google Scholar] [CrossRef] [PubMed]
- Di Martino, P. Extracellular polymeric substances, a key element in understanding biofilm phenotype. AIMS Microbiol. 2018, 4, 274. [Google Scholar] [CrossRef] [PubMed]
- Hall, M.R.; McGillicuddy, E.; Kaplan, L.J. Biofilm: Basic principles, pathophysiology, and implications for clinicians. Surg. Infect. 2014, 15, 1–7. [Google Scholar] [CrossRef]
- Srivastava, S.; Bhargava, A. Biofilms and human health. Biotechnol. Lett. 2016, 38, 1–22. [Google Scholar] [CrossRef]
- Büttner, H.; Mack, D.; Rohde, H. Structural basis of Staphylococcus epidermidis biofilm formation: Mechanisms and molecular interactions. Front. Cell. Infect. Microbiol. 2015, 5, 14. [Google Scholar]
- Irie, Y.; Borlee, B.R.; O’Connor, J.R.; Hill, P.J.; Harwood, C.S.; Wozniak, D.J.; Parsek, M.R. Self-produced exopolysaccharide is a signal that stimulates biofilm formation in Pseudomonas aeruginosa. Proc. Natl. Acad. Sci. USA 2012, 109, 20632–20636. [Google Scholar] [CrossRef] [Green Version]
- Rimondini, L.; Cochis, A.; Varoni, E.; Azzimonti, B.; Carrassi, A. Biofilm formation on implants and prosthetic dental materials. In Handbook of Bioceramics and Biocomposites; Elsevier: Amsterdam, The Netherlands, 2015; pp. 1–37. [Google Scholar]
- Bjarnsholt, T. The role of bacterial biofilms in chronic infections. Apmis 2013, 121, 1–58. [Google Scholar] [CrossRef] [PubMed]
- Del Pozo, J.; Patel, R. The challenge of treating biofilm-associated bacterial infections. Clin. Pharmacol. Ther. 2007, 82, 204–209. [Google Scholar] [CrossRef]
- VanEpps, J.S.; Younger, J.G. Implantable device related infection. Shock 2016, 46, 597. [Google Scholar] [CrossRef] [Green Version]
- De la Fuente-Núñez, C.; Reffuveille, F.; Fernández, L.; Hancock, R.E. Bacterial biofilm development as a multicellular adaptation: Antibiotic resistance and new therapeutic strategies. Curr. Opin. Microbiol. 2013, 16, 580–589. [Google Scholar] [CrossRef]
- Zheng, S.; Bawazir, M.; Dhall, A.; Kim, H.-E.; He, L.; Heo, J.; Hwang, G. Implication of surface properties, bacterial motility, and hydrodynamic conditions on bacterial surface sensing and their initial adhesion. Front. Bioeng. Biotechnol. 2021, 9, 643722. [Google Scholar] [CrossRef] [PubMed]
- Rummel, C.D.; Lechtenfeld, O.J.; Kallies, R.; Benke, A.; Herzsprung, P.; Rynek, R.; Wagner, S.; Potthoff, A.; Jahnke, A.; Schmitt-Jansen, M. Conditioning film and early biofilm succession on plastic surfaces. Environ. Sci. Technol. 2021, 55, 11006–11018. [Google Scholar] [CrossRef]
- Lorite, G.S.; Rodrigues, C.M.; De Souza, A.A.; Kranz, C.; Mizaikoff, B.; Cotta, M.A. The role of conditioning film formation and surface chemical changes on Xylella fastidiosa adhesion and biofilm evolution. J. Colloid Interface Sci. 2011, 359, 289–295. [Google Scholar] [CrossRef] [PubMed] [Green Version]
- Hwang, G.; Liang, J.; Kang, S.; Tong, M.; Liu, Y. The role of conditioning film formation in Pseudomonas aeruginosa PAO1 adhesion to inert surfaces in aquatic environments. Biochem. Eng. J. 2013, 76, 90–98. [Google Scholar] [CrossRef]
- Bhagwat, G.; O’Connor, W.; Grainge, I.; Palanisami, T. Understanding the fundamental basis for biofilm formation on plastic surfaces: Role of conditioning films. Front. Microbiol. 2021, 12, 687118. [Google Scholar] [CrossRef]
- Talluri, S.N.; Winter, R.M.; Salem, D.R. Conditioning film formation and its influence on the initial adhesion and biofilm formation by a cyanobacterium on photobioreactor materials. Biofouling 2020, 36, 183–199. [Google Scholar] [CrossRef]
- Cooksey, K.; Wigglesworth-Cooksey, B. Adhesion of bacteria and diatoms to surfaces in the sea: A review. Aquat. Microb. Ecol. 1995, 9, 87–96. [Google Scholar] [CrossRef]
- Ammar, Y.; Swailes, D.; Bridgens, B.; Chen, J. Influence of surface roughness on the initial formation of biofilm. Surf. Coat. Technol. 2015, 284, 410–416. [Google Scholar] [CrossRef] [Green Version]
- Spengler, C.; Nolle, F.; Mischo, J.; Faidt, T.; Grandthyll, S.; Thewes, N.; Koch, M.; Müller, F.; Bischoff, M.; Klatt, M.A. Strength of bacterial adhesion on nanostructured surfaces quantified by substrate morphometry. Nanoscale 2019, 11, 19713–19722. [Google Scholar] [CrossRef] [Green Version]
- Cao, L.; Chen, X.; Peng, Y. The adsorption and orientation of frother surfactants on heterogeneous wetting surfaces. Appl. Surf. Sci. 2021, 548, 149225. [Google Scholar] [CrossRef]
- Krasowska, A.; Sigler, K. How microorganisms use hydrophobicity and what does this mean for human needs? Front. Cell. Infect. Microbiol. 2014, 4, 112. [Google Scholar] [CrossRef] [PubMed] [Green Version]
- Riau, A.K.; Aung, T.T.; Setiawan, M.; Yang, L.; Yam, H.F.G.; Beuerman, W.R.; Venkatraman, S.S.; Mehta, S.J. Surface immobilization of nano-silver on polymeric medical devices to prevent bacterial biofilm formation. Pathogens 2019, 8, 93. [Google Scholar] [CrossRef] [PubMed] [Green Version]
- Aiyer, K.S.; Vijayakumar, B.; Vishwanathan, A. The enigma of biofilms. Curr. Sci. 2018, 115, 204–205. [Google Scholar] [CrossRef]
- Wang, L.; Fan, D.; Chen, W.; Terentjev, E.M. Bacterial growth, detachment and cell size control on polyethylene terephthalate surfaces. Sci. Rep. 2015, 5, 15159. [Google Scholar] [CrossRef] [Green Version]
- Lagage, V.; Uphoff, S. Filming flagella and pili in action. Nat. Rev. Microbiol. 2018, 16, 584. [Google Scholar] [CrossRef] [PubMed]
- Mérian, T.; Goddard, J.M. Advances in nonfouling materials: Perspectives for the food industry. J. Agric. Food Chem. 2012, 60, 2943–2957. [Google Scholar] [CrossRef] [PubMed]
- Feng, G.; Cheng, Y.; Wang, S.-Y.; Borca-Tasciuc, D.A.; Worobo, R.W.; Moraru, C.I. Bacterial attachment and biofilm formation on surfaces are reduced by small-diameter nanoscale pores: How small is small enough? npj Biofilms Microbiomes 2015, 1, 1–9. [Google Scholar] [CrossRef] [PubMed] [Green Version]
- Abdallah, M.; Benoliel, C.; Drider, D.; Dhulster, P.; Chihib, N.-E. Biofilm formation and persistence on abiotic surfaces in the context of food and medical environments. Arch. Microbiol. 2014, 196, 453–472. [Google Scholar] [CrossRef]
- Greer, H.M.; Overton, K.; Ferguson, M.A.; Spain, E.M.; Darling, L.E.; Núñez, M.E.; Volle, C.B. Extracellular Polymeric Substance Protects Some Cells in an Escherichia coli Biofilm from the Biomechanical Consequences of Treatment with Magainin 2. Microorganisms 2021, 9, 976. [Google Scholar] [CrossRef]
- Mukherjee, S.; Bassler, B.L. Bacterial quorum sensing in complex and dynamically changing environments. Nat. Rev. Microbiol. 2019, 17, 371–382. [Google Scholar] [CrossRef] [PubMed]
- Schaechter, M. Encyclopedia of Microbiology; Academic Press: Cambridge, MA, USA, 2009. [Google Scholar]
- Strycharz-Glaven, S.M.; Snider, R.M.; Guiseppi-Elie, A.; Tender, L.M. On the electrical conductivity of microbial nanowires and biofilms. Energy Environ. Sci. 2011, 4, 4366–4379. [Google Scholar] [CrossRef]
- Neu, J.; Shipps, C.C.; Guberman-Pfeffer, M.J.; Shen, C.; Srikanth, V.; Spies, J.A.; Kirchhofer, N.D.; Yalcin, S.E.; Brudvig, G.W.; Batista, V.S. Microbial biofilms as living photoconductors due to ultrafast electron transfer in cytochrome OmcS nanowires. Nat. Commun. 2022, 13, 5150. [Google Scholar] [CrossRef]
- Reguera, G. Microbial nanowires and electroactive biofilms. FEMS Microbiol. Ecol. 2018, 94, fiy086. [Google Scholar] [CrossRef] [PubMed]
- Ye, Y.; Liu, X.; Nealson, K.H.; Rensing, C.; Qin, S.; Zhou, S. Dissecting the structural and conductive functions of nanowires in Geobacter sulfurreducens electroactive biofilms. mBio 2022, 13, e03822-21. [Google Scholar] [CrossRef] [PubMed]
- Sauer, K.; Cullen, M.; Rickard, A.; Zeef, L.; Davies, D.G.; Gilbert, P. Characterization of nutrient-induced dispersion in Pseudomonas aeruginosa PAO1 biofilm. J. Bacteriol. 2004, 186, 7312–7326. [Google Scholar] [CrossRef] [Green Version]
- Machineni, L.; Rajapantul, A.; Nandamuri, V.; Pawar, P.D. Influence of nutrient availability and quorum sensing on the formation of metabolically inactive microcolonies within structurally heterogeneous bacterial biofilms: An individual-based 3D cellular automata model. Bull. Math. Biol. 2017, 79, 594–618. [Google Scholar] [CrossRef]
- Landini, P.; Antoniani, D.; Burgess, J.G.; Nijland, R. Molecular mechanisms of compounds affecting bacterial biofilm formation and dispersal. Appl. Microbiol. Biotechnol. 2010, 86, 813–823. [Google Scholar] [CrossRef] [PubMed]
- Vilain, S.; Cosette, P.; Zimmerlin, I.; Dupont, J.-P.; Junter, G.-A.; Jouenne, T. Biofilm proteome: Homogeneity or versatility? J. Proteome Res. 2004, 3, 132–136. [Google Scholar] [CrossRef] [PubMed]
- Bowler, P.; Murphy, C.; Wolcott, R. Biofilm exacerbates antibiotic resistance: Is this a current oversight in antimicrobial stewardship? Antimicrob. Resist. Infect. Control 2020, 9, 1–5. [Google Scholar] [CrossRef] [PubMed]
- Yi, L.; Jin, M.; Li, J.; Grenier, D.; Wang, Y. Antibiotic resistance related to biofilm formation in Streptococcus suis. Appl. Microbiol. Biotechnol. 2020, 104, 8649–8660. [Google Scholar] [CrossRef] [PubMed]
- Fauzia, K.A.; Miftahussurur, M.; Syam, A.F.; Waskito, L.A.; Doohan, D.; Rezkitha, Y.A.A.; Matsumoto, T.; Tuan, V.P.; Akada, J.; Yonezawa, H. Biofilm formation and antibiotic resistance phenotype of Helicobacter pylori clinical isolates. Toxins 2020, 12, 473. [Google Scholar] [CrossRef]
- Pereira, R.; dos Santos Fontenelle, R.; De Brito, E.; De Morais, S. Biofilm of Candida albicans: Formation, regulation and resistance. J. Appl. Microbiol. 2021, 131, 11–22. [Google Scholar] [CrossRef]
- Abriat, C.; Gazil, O.; Heuzey, M.-C.; Daigle, F.; Virgilio, N. The polymeric matrix composition of Vibrio cholerae biofilms modulate resistance to silver nanoparticles prepared by hydrothermal synthesis. ACS Appl. Mater. Interfaces 2021, 13, 35356–35364. [Google Scholar] [CrossRef]
- Uruén, C.; Chopo-Escuin, G.; Tommassen, J.; Mainar-Jaime, R.C.; Arenas, J. Biofilms as promoters of bacterial antibiotic resistance and tolerance. Antibiotics 2020, 10, 3. [Google Scholar] [CrossRef]
- Goel, N.; Fatima, S.W.; Kumar, S.; Sinha, R.; Khare, S.K. Antimicrobial resistance in biofilms: Exploring marine actinobacteria as a potential source of antibiotics and biofilm inhibitors. Biotechnol. Rep. 2021, 30, e00613. [Google Scholar] [CrossRef]
- Piras, C.; Di Ciccio, P.A.; Soggiu, A.; Greco, V.; Tilocca, B.; Costanzo, N.; Ceniti, C.; Urbani, A.; Bonizzi, L.; Ianieri, A.S. aureus biofilm protein expression linked to antimicrobial resistance: A proteomic study. Animals 2021, 11, 966. [Google Scholar] [CrossRef] [PubMed]
- Gilbert, P.; Allison, D.; McBain, A. Biofilms in vitro and in vivo: Do singular mechanisms imply cross-resistance? J. Appl. Microbiol. 2002, 92, 98S–110S. [Google Scholar] [CrossRef]
- Yadav, M.K.; Song, J.-J.; Singh, B.P.; Vidal, J.E. Microbial biofilms and human disease: A concise review. New Future Dev. Microb. Biotechnol. Bioeng. Microb. Biofilms 2020, 1, 1–13. [Google Scholar]
- Li, Y.; Xiao, P.; Wang, Y.; Hao, Y. Mechanisms and control measures of mature biofilm resistance to antimicrobial agents in the clinical context. ACS Omega 2020, 5, 22684–22690. [Google Scholar] [CrossRef] [PubMed]
- Donlan, R.M. Biofilm formation: A clinically relevant microbiological process. Clin. Infect. Dis. 2001, 33, 1387–1392. [Google Scholar] [CrossRef] [PubMed] [Green Version]
- Kostakioti, M.; Hadjifrangiskou, M.; Hultgren, S.J. Bacterial biofilms: Development, dispersal, and therapeutic strategies in the dawn of the postantibiotic era. Cold Spring Harb. Perspect. Med. 2013, 3, a010306. [Google Scholar] [CrossRef] [PubMed] [Green Version]
- Davey, M.E.; O’toole, G.A. Microbial biofilms: From ecology to molecular genetics. Microbiol. Mol. Biol. Rev. 2000, 64, 847–867. [Google Scholar] [CrossRef] [Green Version]
- Swartjes, J.J.; Das, T.; Sharifi, S.; Subbiahdoss, G.; Sharma, P.K.; Krom, B.P.; Busscher, H.J.; van der Mei, H.C. A functional DNase I coating to prevent adhesion of bacteria and the formation of biofilm. Adv. Funct. Mater. 2013, 23, 2843–2849. [Google Scholar] [CrossRef]
- Costerton, J.W.; Lewandowski, Z.; Caldwell, D.E.; Korber, D.R.; Lappin-Scott, H.M. Microbial biofilms. Annu. Rev. Microbiol. 1995, 49, 711–745. [Google Scholar] [CrossRef]
- Stewart, P.S. Diffusion in biofilms. J. Bacteriol. 2003, 185, 1485–1491. [Google Scholar] [CrossRef] [PubMed] [Green Version]
- Smirnova, T.; Didenko, L.; Azizbekyan, R.; Romanova, Y.M. Structural and functional characteristics of bacterial biofilms. Microbiology 2010, 79, 413–423. [Google Scholar] [CrossRef]
- Saini, R.; Giri, P.; Saini, S.; Saini, S. Dental Plaque: A Complex Biofilm. Pravara Med. Rev. 2015, 7, 9–14. [Google Scholar]
- Carette, J.; Nachtergael, A.; Duez, P.; El Jaziri, M.; Rasamiravaka, T. Natural compounds inhibiting Pseudomonas aeruginosa biofilm formation by targeting quorum sensing circuitry. Bact. Biofilms 2020. [Google Scholar] [CrossRef] [Green Version]
- Fanning, S.; Mitchell, A.P. Fungal biofilms. PLoS Pathog. 2012, 8, e1002585. [Google Scholar] [CrossRef] [Green Version]
- Ruiz, A.; Herráez, M.; Costa-Gutierrez, S.B.; Molina-Henares, M.A.; Martínez, M.J.; Espinosa-Urgel, M.; Barriuso, J. The architecture of a mixed fungal–bacterial biofilm is modulated by quorum-sensing signals. Environ. Microbiol. 2021, 23, 2433–2447. [Google Scholar] [CrossRef]
- Gutiérrez, D.; Rodríguez-Rubio, L.; Martínez, B.; Rodríguez, A.; García, P. Bacteriophages as weapons against bacterial biofilms in the food industry. Front. Microbiol. 2016, 7, 825. [Google Scholar] [CrossRef] [Green Version]
- Colavecchio, A.; Cadieux, B.; Lo, A.; Goodridge, L.D. Bacteriophages contribute to the spread of antibiotic resistance genes among foodborne pathogens of the Enterobacteriaceae family—A review. Front. Microbiol. 2017, 8, 1108. [Google Scholar] [CrossRef] [Green Version]
- Khelissa, S.O.; Abdallah, M.; Jama, C.; Faille, C.; Chihib, N.-E. Bacterial contamination and biofilm formation on abiotic surfaces and strategies to overcome their persistence. J. Mater. Environ. Sci. 2017, 8, 3326–3346. [Google Scholar]
- Almaguer-Flores, A. Biofilms in the oral environment. In Bio-Tribocorrosion in Biomaterials and Medical Implants; Elsevier: Amsterdam, The Netherlands, 2013; pp. 169–186. [Google Scholar]
- Archibald, L.; Phillips, L.; Monnet, D.; McGowan, J.E., Jr.; Tenover, F.; Gaynes, R. Antimicrobial resistance in isolates from inpatients and outpatients in the United States: Increasing importance of the intensive care unit. Clin. Infect. Dis. 1997, 24, 211–215. [Google Scholar] [CrossRef] [Green Version]
- Berbari, E.F.; Hanssen, A.D.; Duffy, M.C.; Steckelberg, J.M.; Ilstrup, D.M.; Harmsen, W.S.; Osmon, D.R. Risk factors for prosthetic joint infection: Case-control study. Clin. Infect. Dis. 1998, 27, 1247–1254. [Google Scholar] [CrossRef]
- Almqvist, M.; Mattsson, G.; Razmi, R.; Magnusson, P. Cardiac Implantable Electronic Device-Related Infections. In Infective Endocarditis; IntechOpen: London, UK, 2019. [Google Scholar]
- Kranz, J.; Schmidt, S.; Wagenlehner, F.; Schneidewind, L. Catheter-associated urinary tract infections in adult patients: Preventive strategies and treatment options. Dtsch. Ärzteblatt Int. 2020, 117, 83. [Google Scholar]
- Papazian, L.; Klompas, M.; Luyt, C.-E. Ventilator-associated pneumonia in adults: A narrative review. Intensive Care Med. 2020, 46, 888–906. [Google Scholar] [CrossRef] [Green Version]
- Jacqz-Aigrain, E.; Choonara, I. Paediatric Clinical Pharmacology; CRC Press: Boca Raton, FL, USA, 2021. [Google Scholar]
- Kramer, G.; Klingler, H.C.; Steiner, G.E. Role of bacteria in the development of kidney stones. Curr. Opin. Urol. 2000, 10, 35–38. [Google Scholar] [CrossRef] [PubMed]
- Saini, R.; Marawar, P.; Shete, S.; Saini, S. Periodontitis, a true infection. J. Glob. Infect. Dis. 2009, 1, 149. [Google Scholar] [CrossRef] [PubMed]
- Rajani, R.; Klein, J.L. Infective endocarditis: A contemporary update. Clin. Med. 2020, 20, 31. [Google Scholar] [CrossRef]
- Saiman, L.; Siegel, J. Infection control in cystic fibrosis. Clin. Microbiol. Rev. 2004, 17, 57–71. [Google Scholar] [CrossRef] [Green Version]
- Mancl, K.A.; Kirsner, R.S.; Ajdic, D. Wound biofilms: Lessons learned from oral biofilms. Wound Repair Regen. 2013, 21, 352–362. [Google Scholar] [CrossRef] [Green Version]
- Brandwein, M.; Steinberg, D.; Meshner, S. Microbial biofilms and the human skin microbiome. NPJ Biofilms Microbiomes 2016, 2, 3. [Google Scholar] [CrossRef] [Green Version]
- Coenye, T.; Honraet, K.; Rossel, B.; Nelis, H.J. Biofilms in skin infections: Propionibacterium acnes and acne vulgaris. Infect. Disord. -Drug Targets Former. Curr. Drug Targets-Infect. Disord. 2008, 8, 156–159. [Google Scholar] [CrossRef]
- Di Domenico, E.; Cavallo, I.; Bordignon, V.; Prignano, G.; Sperduti, I.; Gurtner, A.; Trento, E.; Toma, L.; Pimpinelli, F.; Capitanio, B. Inflammatory cytokines and biofilm production sustain Staphylococcus aureus outgrowth and persistence: A pivotal interplay in the pathogenesis of Atopic Dermatitis. Sci. Rep. 2018, 8, 9573. [Google Scholar] [CrossRef] [PubMed] [Green Version]
- Rajpaul, K. Biofilm in wound care. Br. J. Community Nurs. 2015, 20, S6–S11. [Google Scholar] [CrossRef] [PubMed]
- Shineh, G.; Kordestani, S.S.; Tahriri, M.; Tayebi, L. Evaluation of L929 cell morphology on anthocyanin-containing gelatin-based hydrogel for early detection of infection. Bio-Des. Manuf. 2019, 2, 181–186. [Google Scholar] [CrossRef]
- Agyingi, E.; Maggelakis, S.; Ross, D. The effect of bacteria on epidermal wound healing. Math. Model. Nat. Phenom. 2010, 5, 28–39. [Google Scholar] [CrossRef] [Green Version]
- Rossi, E.; La Rosa, R.; Bartell, J.A.; Marvig, R.L.; Haagensen, J.A.; Sommer, L.M.; Molin, S.; Johansen, H.K. Pseudomonas aeruginosa adaptation and evolution in patients with cystic fibrosis. Nat. Rev. Microbiol. 2021, 19, 331–342. [Google Scholar] [CrossRef]
- Costerton, J.W.; Stewart, P.S.; Greenberg, E.P. Bacterial biofilms: A common cause of persistent infections. Science 1999, 284, 1318–1322. [Google Scholar] [CrossRef] [Green Version]
- Roberts, C.G. The role of biofilms in reprocessing medical devices. Am. J. Infect. Control 2013, 41, S77–S80. [Google Scholar] [CrossRef]
- Pearle, M.S.; Roehrborn, C.G. Antimicrobial prophylaxis prior to shock wave lithotripsy in patients with sterile urine before treatment: A meta-analysis and cost-effectiveness analysis. Urology 1997, 49, 679–686. [Google Scholar] [CrossRef]
- Ciofu, O.; Rojo-Molinero, E.; Macià, M.D.; Oliver, A. Antibiotic treatment of biofilm infections. Apmis 2017, 125, 304–319. [Google Scholar] [CrossRef] [Green Version]
- Lee, S.W.; Phillips, K.S.; Gu, H.; Kazemzadeh-Narbat, M.; Ren, D. How microbes read the map: Effects of implant topography on bacterial adhesion and biofilm formation. Biomaterials 2021, 268, 120595. [Google Scholar] [CrossRef]
- Pipattanachat, S.; Qin, J.; Rokaya, D.; Thanyasrisung, P.; Srimaneepong, V. Biofilm inhibition and bactericidal activity of NiTi alloy coated with graphene oxide/silver nanoparticles via electrophoretic deposition. Sci. Rep. 2021, 11, 14008. [Google Scholar] [CrossRef] [PubMed]
- Piktel, E.; Suprewicz, Ł.; Depciuch, J.; Chmielewska, S.; Skłodowski, K.; Daniluk, T.; Król, G.; Kołat-Brodecka, P.; Bijak, P.; Pajor-Świerzy, A. Varied-shaped gold nanoparticles with nanogram killing efficiency as potential antimicrobial surface coatings for the medical devices. Sci. Rep. 2021, 11, 12546. [Google Scholar] [CrossRef] [PubMed]
- Tang, M.; Chen, C.; Zhu, J.; Allcock, H.R.; Siedlecki, C.A.; Xu, L.-C. Inhibition of bacterial adhesion and biofilm formation by a textured fluorinated alkoxyphosphazene surface. Bioact. Mater. 2021, 6, 447–459. [Google Scholar] [CrossRef] [PubMed]
- Nagay, B.E.; Dini, C.; Cordeiro, J.M.; Ricomini-Filho, A.n.P.; De Avila, E.D.; Rangel, E.C.; Da Cruz, N.C.; Barão, V.A. Visible-light-induced photocatalytic and antibacterial activity of tio2 codoped with nitrogen and bismuth: New perspectives to control implant-biofilm-related diseases. ACS Appl. Mater. Interfaces 2019, 11, 18186–18202. [Google Scholar] [CrossRef]
- Servais, P.; Laurent, P.; Randon, G. Comparison of the bacterial dynamics in various French distribution systems. Aqua-Lond. Oxf. -J. Int. Water Supply Assoc. 1995, 44, 10. [Google Scholar]
- September, S.; Els, F.; Venter, S.; Brözel, V. Prevalence of bacterial pathogens in biofilms of drinking water distribution systems. J. Water Health 2007, 5, 219–227. [Google Scholar] [CrossRef] [Green Version]
- Lee, S.H.; O’Connor, J.T.; Banerji, S.K. Biologically mediated corrosion and its effects on water quality in distribution systems. J. Am. Water Work. Assoc. 1980, 72, 636–645. [Google Scholar] [CrossRef]
- Levy, R.V.; Hart, F.L.; Cheetham, R.D. Occurrence and public health significance of invertebrates in drinking water systems. J. Am. Water Work. Assoc. 1986, 78, 105–110. [Google Scholar] [CrossRef]
- Tsvetanova, Z. Study of biofilm formation on different pipe materials in a model of drinking water distribution system and its impact on microbiological water quality. In Chemicals as Intentional and Accidental Global Environmental Threats; Springer: Dordrecht, The Netherlands, 2006; pp. 463–468. [Google Scholar]
- Hallam, N.; West, J.; Forster, C.; Simms, J. The potential for biofilm growth in water distribution systems. Water Res. 2001, 35, 4063–4071. [Google Scholar] [CrossRef]
- Ren, H.; Wang, W.; Liu, Y.; Liu, S.; Lou, L.; Cheng, D.; He, X.; Zhou, X.; Qiu, S.; Fu, L. Pyrosequencing analysis of bacterial communities in biofilms from different pipe materials in a city drinking water distribution system of East China. Appl. Microbiol. Biotechnol. 2015, 99, 10713–10724. [Google Scholar] [CrossRef]
- Cowle, M.W.; Webster, G.; Babatunde, A.O.; Bockelmann-Evans, B.N.; Weightman, A.J. Impact of flow hydrodynamics and pipe material properties on biofilm development within drinking water systems. Environ. Technol. 2020, 41, 3732–3744. [Google Scholar] [CrossRef] [PubMed] [Green Version]
- Tsagkari, E.; Sloan, W. Turbulence accelerates the growth of drinking water biofilms. Bioprocess Biosyst. Eng. 2018, 41, 757–770. [Google Scholar] [CrossRef] [Green Version]
- Ercumen, A.; Gruber, J.S.; Colford, J.M., Jr. Water distribution system deficiencies and gastrointestinal illness: A systematic review and meta-analysis. Environ. Health Perspect. 2014, 122, 651–660. [Google Scholar] [CrossRef] [PubMed] [Green Version]
- Semenza, J.C.; Roberts, L.; Henderson, A.; Bogan, J.; Rubin, C. Water distribution system and diarrheal disease transmission: A case study in Uzbekistan. Am. J. Trop. Med. Hyg. 1998, 59, 941–946. [Google Scholar] [CrossRef] [PubMed]
- Percival, S.L.; Chalmers, R.; Hunter, P.R.; Sellwood, J.; Wyn-Jones, P. Microbiology of Waterborne Diseases; Elsevier: Amsterdam, The Netherlands; Academic Press: Cambridge, MA, USA, 2004; Volume 92101. [Google Scholar]
- Payment, P. Epidemiology of endemic gastrointestinal and respiratory diseases: Incidence, fraction attributable to tap water and costs to society. Water Sci. Technol. 1997, 35, 7–10. [Google Scholar] [CrossRef]
- Simoes, L.C.; Simões, M. Biofilms in drinking water: Problems and solutions. Rsc Adv. 2013, 3, 2520–2533. [Google Scholar] [CrossRef] [Green Version]
- de Faria, A.F.; Martinez, D.S.T.; Meira, S.M.M.; de Moraes, A.C.M.; Brandelli, A.; Souza Filho, A.G.; Alves, O.L. Anti-adhesion and antibacterial activity of silver nanoparticles supported on graphene oxide sheets. Colloids Surf. B Biointerfaces 2014, 113, 115–124. [Google Scholar] [CrossRef]
- Shi, X.; Zhu, X. Biofilm formation and food safety in food industries. Trends Food Sci. Technol. 2009, 20, 407–413. [Google Scholar] [CrossRef]
- Wang, H.; Wang, H.; Xing, T.; Wu, N.; Xu, X.; Zhou, G. Removal of Salmonella biofilm formed under meat processing environment by surfactant in combination with bio-enzyme. LWT-Food Sci. Technol. 2016, 66, 298–304. [Google Scholar] [CrossRef]
- Mafu, A.A.; Plumety, C.; Deschênes, L.; Goulet, J. Adhesion of pathogenic bacteria to food contact surfaces: Influence of pH of culture. Int. J. Microbiol. 2011, 2011, 972494. [Google Scholar] [CrossRef] [Green Version]
- Galie, S.; García-Gutiérrez, C.; Miguélez, E.M.; Villar, C.J.; Lombó, F. Biofilms in the food industry: Health aspects and control methods. Front. Microbiol. 2018, 9, 898. [Google Scholar] [CrossRef]
- Król, Ż.; Jarmoluk, A. The effects of using a direct electric current on the chemical properties of gelatine gels and bacterial growth. J. Food Eng. 2016, 170, 1–7. [Google Scholar] [CrossRef]
- Kumar, S.; Mukherjee, A.; Dutta, J. Chitosan based nanocomposite films and coatings: Emerging antimicrobial food packaging alternatives. Trends Food Sci. Technol. 2020, 97, 196–209. [Google Scholar] [CrossRef]
- Rengaraju, B.; Jeevanantham, M.; Shanmugaraja, S.; Selvakumar, A.; Tamilselvi, S. Evaluation of mechanical and antimicrobial properties for indigenously developed Biofilm for food packaging industries. In Proceedings of IOP Conference Series: Materials Science and Engineering; IOP Publishing: Bristol, UK, 2023; p. 012001. [Google Scholar]
- Chopra, L.; Singh, G.; Kumar Jena, K.; Sahoo, D.K. Sonorensin: A new bacteriocin with potential of an anti-biofilm agent and a food biopreservative. Sci. Rep. 2015, 5, 13412. [Google Scholar] [CrossRef] [PubMed] [Green Version]
- Lewandowski, Z.; Boltz, J.P. Biofilms in water and wastewater treatment. In Treatise on Water Science; Elsevier: Amsterdam, The Netherlands, 2011. [Google Scholar]
- Szostak-Kotowa, J. Biodeterioration of textiles. Int. Biodeterior. Biodegrad. 2004, 53, 165–170. [Google Scholar] [CrossRef]
- Ramachandran, T.; Kumar, R.; Rajendran, R. Antimicrobial textiles—An overview. J. Inst. Eng. Part TX Text. Eng. Div. 2004, 84, 42–47. [Google Scholar]
- Buschle-Diller, G.; Zeronian, S.; Pan, N.; Yoon, M. Enzymatic hydrolysis of cotton, linen, ramie, and viscose rayon fabrics. Text. Res. J. 1994, 64, 270–279. [Google Scholar] [CrossRef]
- Nosaka, Y.; Koenuma, K.; Ushida, K.; Kira, A. Reaction mechanism of the decomposition of acetic acid on illuminated TiO2 powder studied by means of in situ electron spin resonance measurements. Langmuir 1996, 12, 736–738. [Google Scholar] [CrossRef]
- Anghel, I.; Grumezescu, A.M.; Andronescu, E.; Anghel, A.G.; Ficai, A.; Saviuc, C.; Grumezescu, V.; Vasile, B.S.; Chifiriuc, M.C. Magnetite nanoparticles for functionalized textile dressing to prevent fungal biofilms development. Nanoscale Res. Lett. 2012, 7, 1–6. [Google Scholar] [CrossRef] [PubMed] [Green Version]
- Parker, C. The Corrosion of Concrete 1. The Isolation of a Species of Bacterium Associated with the Corrosion of Concrete Exposed to Atmospheres Containing Hydrogen Sulphide. Aust. J. Exp. Biol. Med. Sci. 1945, 23, 81–90. [Google Scholar] [CrossRef]
- George, R.; Ramya, S.; Ramachandran, D.; Mudali, U.K. Studies on Biodegradation of normal concrete surfaces by fungus Fusarium sp. Cem. Concr. Res. 2013, 47, 8–13. [Google Scholar] [CrossRef]
- Kumari, K.; Preetha, R.; Ramachandran, D.; Vishwakarma, V.; George, R.P.; Sundaramurthy, C.; Mudali, U.K.; Pillai, C.S. Nanoparticles for enhancing mechanical properties of fly ash concrete. Mater. Today Proc. 2016, 3, 2387–2393. [Google Scholar] [CrossRef]
- Vishwakarma, V.; Sudha, U.; Ramachandran, D.; Anandkumar, B.; George, R.; Kumari, K.; Preetha, R.; Mudali, U.K.; Pillai, C. Enhancing antimicrobial properties of fly ash mortars specimens through nanophase modification. Mater. Today Proc. 2016, 3, 1389–1397. [Google Scholar] [CrossRef]
- Vishwakarma, V. Impact of environmental biofilms: Industrial components and its remediation. J. Basic Microbiol. 2020, 60, 198–206. [Google Scholar] [CrossRef] [PubMed]
- Enning, D.; Garrelfs, J. Corrosion of iron by sulfate-reducing bacteria: New views of an old problem. Appl. Environ. Microbiol. 2014, 80, 1226–1236. [Google Scholar] [CrossRef] [Green Version]
- Therasa, J.J.; Vishwakarma, V.; George, R.; Kamruddin, M.; Kalavathi, S.; Manoharan, N.; Tyagi, A.; Dayal, R. Reducing biofouling on titanium surface by electroless deposition of antibacterial copper nano films. Curr. Sci. 2010, 99, 1079–1083. [Google Scholar]
- Vishwakarma, V.; Josephine, J.; George, R.; Krishnan, R.; Dash, S.; Kamruddin, M.; Kalavathi, S.; Manoharan, N.; Tyagi, A.; Dayal, R. Antibacterial copper–nickel bilayers and multilayer coatings by pulsed laser deposition on titanium. Biofouling 2009, 25, 705–710. [Google Scholar] [CrossRef] [PubMed]
- Thorlaksen, P.; Yebra, D.M.; Català, P. Hydrogel-Based Third Generation Fouling Release Coatings; Royal Belgian Institute of Marine Engineers: Brusselsestraat, Belgium, 2010. [Google Scholar]
- De Carvalho, C.C. Marine biofilms: A successful microbial strategy with economic implications. Front. Mar. Sci. 2018, 5, 126. [Google Scholar] [CrossRef] [Green Version]
- Rascio, V.J. Antifouling coatings: Where do we go from here. Corros. Rev. 2000, 18, 133–154. [Google Scholar] [CrossRef]
- Selim, M.S.; Shenashen, M.; El-Safty, S.A.; Higazy, S.; Selim, M.M.; Isago, H.; Elmarakbi, A. Recent progress in marine foul-release polymeric nanocomposite coatings. Prog. Mater. Sci. 2017, 87, 1–32. [Google Scholar] [CrossRef]
- Rondeau, D. Synthesis and Application of Cellulose-Based Hydrogels for Anti-Biofouling in Marine Environments; University of Maine: Orono, ME, USA, 2019. [Google Scholar]
- Abioye, O.P.; Loto, C.; Fayomi, O. Evaluation of anti-biofouling progresses in marine application. J. Bio-Tribo-Corros. 2019, 5, 22. [Google Scholar] [CrossRef]
- Kirschner, C.M.; Brennan, A.B. Bio-inspired antifouling strategies. Annu. Rev. Mater. Res. 2012, 42, 211–229. [Google Scholar] [CrossRef]
- Basu, S.; Hanh, B.M.; Chua, J.I.; Daniel, D.; Ismail, M.H.; Marchioro, M.; Amini, S.; Rice, S.A.; Miserez, A. Green biolubricant infused slippery surfaces to combat marine biofouling. J. Colloid Interface Sci. 2020, 568, 185–197. [Google Scholar] [CrossRef]
- Liu, C.; Ma, C.; Xie, Q.; Zhang, G. Self-repairing silicone coatings for marine anti-biofouling. J. Mater. Chem. A 2017, 5, 15855–15861. [Google Scholar] [CrossRef]
- Guo, H.; Yang, J.; Zhao, W.; Xu, T.; Lin, C.; Zhang, J.; Zhang, L. Direct formation of amphiphilic crosslinked networks based on PVP as a marine anti-biofouling coating. Chem. Eng. J. 2019, 374, 1353–1363. [Google Scholar] [CrossRef]
- Zhao, W.; Yang, J.; Guo, H.; Xu, T.; Li, Q.; Wen, C.; Sui, X.; Lin, C.; Zhang, J.; Zhang, L. Slime-resistant marine anti-biofouling coating with PVP-based copolymer in PDMS matrix. Chem. Eng. Sci. 2019, 207, 790–798. [Google Scholar] [CrossRef]
- Ciriminna, R.; Bright, F.V.; Pagliaro, M. Ecofriendly Antifouling Marine Coatings; ACS Publications: Washington, DC, USA, 2015. [Google Scholar]
- Xie, C.; Li, C.; Xie, Y.; Cao, Z.; Li, S.; Zhao, J.; Wang, M. ZnO/acrylic polyurethane nanocomposite superhydrophobic coating on aluminum substrate obtained via spraying and Co-curing for the control of marine biofouling. Surf. Interfaces 2021, 22, 100833. [Google Scholar] [CrossRef]
- Almeida, E.; Diamantino, T.C.; de Sousa, O. Marine paints: The particular case of antifouling paints. Prog. Org. Coat. 2007, 59, 2–20. [Google Scholar] [CrossRef]
- Stupak, M.E.; García, M.T.; Pérez, M.C. Non-toxic alternative compounds for marine antifouling paints. Int. Biodeterior. Biodegrad. 2003, 52, 49–52. [Google Scholar] [CrossRef]
- Braga, C.; Hunsucker, K.; Gardner, H.; Swain, G. A novel design to investigate the impacts of UV exposure on marine biofouling. Appl. Ocean Res. 2020, 101, 102226. [Google Scholar] [CrossRef]
- Neely, A.N.; Maley, M.P. Survival of enterococci and staphylococci on hospital fabrics and plastic. J. Clin. Microbiol. 2000, 38, 724–726. [Google Scholar] [CrossRef] [PubMed] [Green Version]
- Boyce, J.M.; Potter-Bynoe, G.; Chenevert, C.; King, T. Environmental contamination due to methicillin-resistant Staphylococcus aureus possible infection control implications. Infect. Control Hosp. Epidemiol. 1997, 18, 622–627. [Google Scholar] [CrossRef] [PubMed]
- De Beer, D.; Srinivasan, R.; Stewart, P.S. Direct measurement of chlorine penetration into biofilms during disinfection. Appl. Environ. Microbiol. 1994, 60, 4339–4344. [Google Scholar] [CrossRef] [PubMed] [Green Version]
- Mosteller, T.M.; Bishop, J.R. Sanitizer Efficacy Against Attached Bacteria in a Milk Biofilm. J. Food Prot. 1993, 56, 34–41. [Google Scholar] [CrossRef]
- Johansen, C.; Falholt, P.; Gram, L. Enzymatic removal and disinfection of bacterial biofilms. Appl. Environ. Microbiol. 1997, 63, 3724–3728. [Google Scholar] [CrossRef] [Green Version]
- Fatemi, P.; Frank, J.F. Inactivation of Listeria monocytogenes/Pseudomonas biofilms by peracid sanitizers. J. Food Prot. 1999, 62, 761–765. [Google Scholar] [CrossRef]
- Bloomfield, S.; Uso, E. The antibacterial properties of sodium hypochlorite and sodium dichloroisocyanurate as hospital disinfectants. J. Hosp. Infect. 1985, 6, 20–30. [Google Scholar] [CrossRef]
- Bloomfield, S.F.; Arthur, M. Interaction of Bacillus subtilis spores with sodium hypochlorite, sodium dichloroisocyanurate and chloramine-T. J. Appl. Microbiol. 1992, 72, 166–172. [Google Scholar] [CrossRef]
- Finnegan, M.; Linley, E.; Denyer, S.P.; McDonnell, G.; Simons, C.; Maillard, J.-Y. Mode of action of hydrogen peroxide and other oxidizing agents: Differences between liquid and gas forms. J. Antimicrob. Chemother. 2010, 65, 2108–2115. [Google Scholar] [CrossRef] [Green Version]
- Skowron, K.; Wałecka-Zacharska, E.; Grudlewska, K.; Białucha, A.; Wiktorczyk, N.; Bartkowska, A.; Kowalska, M.; Kruszewski, S.; Gospodarek-Komkowska, E. Biocidal effectiveness of selected disinfectants solutions based on water and ozonated water against Listeria monocytogenes strains. Microorganisms 2019, 7, 127. [Google Scholar] [CrossRef] [Green Version]
- Schwaiger, K.; Harms, K.S.; Bischoff, M.; Preikschat, P.; Mölle, G.; Bauer-Unkauf, I.; Lindorfer, S.; Thalhammer, S.; Bauer, J.; Hölzel, C.S. Insusceptibility to disinfectants in bacteria from animals, food and humans—Is there a link to antimicrobial resistance? Front. Microbiol. 2014, 5, 88. [Google Scholar] [CrossRef] [Green Version]
- Fukuzaki, S. Mechanisms of actions of sodium hypochlorite in cleaning and disinfection processes. Biocontrol Sci. 2006, 11, 147–157. [Google Scholar] [CrossRef]
- Kulik, E.M.; Waltimo, T.; Weiger, R.; Schweizer, I.; Lenkeit, K.; Filipuzzi-Jenny, E.; Walter, C. Development of resistance of mutans streptococci and Porphyromonas gingivalis to chlorhexidine digluconate and amine fluoride/stannous fluoride-containing mouthrinses, in vitro. Clin. Oral Investig. 2015, 19, 1547–1553. [Google Scholar] [CrossRef]
- Ng, I.-S.; Ooi, C.W.; Liu, B.-L.; Peng, C.-T.; Chiu, C.-Y.; Chang, Y.-K. Antibacterial efficacy of chitosan-and poly (hexamethylene biguanide)-immobilized nanofiber membrane. Int. J. Biol. Macromol. 2020, 154, 844–854. [Google Scholar] [CrossRef]
- Gerba, C.P. Quaternary ammonium biocides: Efficacy in application. Appl. Environ. Microbiol. 2015, 81, 464–469. [Google Scholar] [CrossRef] [Green Version]
- Lineback, C.B.; Nkemngong, C.A.; Wu, S.T.; Li, X.; Teska, P.J.; Oliver, H.F. Hydrogen peroxide and sodium hypochlorite disinfectants are more effective against Staphylococcus aureus and Pseudomonas aeruginosa biofilms than quaternary ammonium compounds. Antimicrob. Resist. Infect. Control 2018, 7, 1–7. [Google Scholar] [CrossRef] [PubMed] [Green Version]
- Xu, P.; Janex, M.-L.; Savoye, P.; Cockx, A.; Lazarova, V. Wastewater disinfection by ozone: Main parameters for process design. Water Res. 2002, 36, 1043–1055. [Google Scholar] [CrossRef] [PubMed]
- Fontes, B.; Cattani Heimbecker, A.M.; de Souza Brito, G.; Costa, S.F.; van der Heijden, I.M.; Levin, A.S.; Rasslan, S. Effect of low-dose gaseous ozone on pathogenic bacteria. BMC Infect. Dis. 2012, 12, 1–6. [Google Scholar] [CrossRef] [PubMed] [Green Version]
- WHO. WHO guidelines on hand hygiene in health care. In WHO Guidelines on Hand Hygiene in Health Care; WHO: Geneva, Switzerland, 2009; p. 270. [Google Scholar]
- Block, S.S. Disinfection, Sterilization, and Preservation; Lippincott Williams & Wilkins: Philadelphia, PE, USA, 2001. [Google Scholar]
- Subhan, A.; Manalu, W.; Rahminiwati, M.; Darusman, H.S. The Study of Quality Evaluation of A Hand Rub (Hand Sanitizer) With Who-Based-Standard Formulation and Percent Reduction of Bacteria (Percentage Kill Bacteria) In Methicillin-Resistant Staphylococcus aureus (MRSA). Indones. J. Pharmacy. 2021, 32, 1252. [Google Scholar] [CrossRef]
- Niemira, B.A.; Solomon, E.B. Sensitivity of planktonic and biofilm-associated Salmonella spp. to ionizing radiation. Appl. Environ. Microbiol. 2005, 71, 2732–2736. [Google Scholar] [CrossRef] [Green Version]
- Vleugels, M.; Shama, G.; Deng, X.T.; Greenacre, E.; Brocklehurst, T.; Kong, M.G. Atmospheric plasma inactivation of biofilm-forming bacteria for food safety control. IEEE Trans. Plasma Sci. 2005, 33, 824–828. [Google Scholar] [CrossRef] [Green Version]
- Oulahal-Lagsir, N.; Martial-Gros, A.; Bonneau, M.; Blum, L.J. “Escherichia coli-milk” biofilm removal from stainless steel surfaces: Synergism between ultrasonic waves and enzymes. Biofueling 2003, 19, 159–168. [Google Scholar]
- Bott, T.; Tianqing, L. Ultrasound enhancement of biocide efficiency. Ultrason. Sonochemistry 2004, 11, 323–326. [Google Scholar] [CrossRef]
- Costerton, J.W.; Ellis, B.; Lam, K.; Johnson, F.; Khoury, A.E. Mechanism of electrical enhancement of efficacy of antibiotics in killing biofilm bacteria. Antimicrob. Agents Chemother. 1994, 38, 2803–2809. [Google Scholar] [CrossRef] [Green Version]
- Javaherdashti, R.; Javaherdashti, R. Microbiologically Influenced Corrosion (MIC); Springer: Berlin/Heidelberg, Germany, 2017. [Google Scholar]
- Dexter, S.; LaFontaine, J. Effect of natural marine biofilms on galvanic corrosion. Corrosion 1998, 54, 851–861. [Google Scholar] [CrossRef]
- Liu, H.; Liu, H.; Zhang, Y. Galvanic corrosion due to a heterogeneous sulfate reducing bacteria biofilm. Coatings 2020, 10, 1116. [Google Scholar] [CrossRef]
- Ornek, D.; Wood, T.; Hsu, C.; Sun, Z.; Mansfeld, F. Pitting corrosion control of aluminum 2024 using protective biofilms that secrete corrosion inhibitors. Corrosion 2002, 58, 761–767. [Google Scholar] [CrossRef]
- Alamri, A.H. Localized corrosion and mitigation approach of steel materials used in oil and gas pipelines—An overview. Eng. Fail. Anal. 2020, 116, 104735. [Google Scholar] [CrossRef]
- Lee, W.; Lewandowski, Z.; Nielsen, P.H.; Hamilton, W.A. Role of sulfate-reducing bacteria in corrosion of mild steel: A review. Biofouling 1995, 8, 165–194. [Google Scholar] [CrossRef]
- Mollica, A. Biofilm and corrosion on active-passive alloys in seawater. Int. Biodeterior. Biodegrad. 1992, 29, 213–229. [Google Scholar] [CrossRef]
- Victoria, S.N.; Sharma, A.; Manivannan, R. Metal corrosion induced by microbial activity–mechanism and control options. J. Indian Chem. Soc. 2021, 98, 100083. [Google Scholar] [CrossRef]
- Little, B.; Ray, R.; Pope, R. Relationship between corrosion and the biological sulfur cycle: A review. Corrosion 2000, 56, 4. [Google Scholar] [CrossRef]
- Mauldin, P.D.; Salgado, C.D.; Hansen, I.S.; Durup, D.T.; Bosso, J.A. Attributable hospital cost and length of stay associated with health care-associated infections caused by antibiotic-resistant gram-negative bacteria. Antimicrob. Agents Chemother. 2010, 54, 109–115. [Google Scholar] [CrossRef] [PubMed] [Green Version]
- Kollef, K.E.; Schramm, G.E.; Wills, A.R.; Reichley, R.M.; Micek, S.T.; Kollef, M.H. Predictors of 30-day mortality and hospital costs in patients with ventilator-associated pneumonia attributed to potentially antibiotic-resistant gram-negative bacteria. Chest 2008, 134, 281–287. [Google Scholar] [CrossRef]
- Magin, C.M.; Cooper, S.P.; Brennan, A.B. Non-toxic antifouling strategies. Mater. Today 2010, 13, 36–44. [Google Scholar] [CrossRef]
- Murosaki, T.; Ahmed, N.; Gong, J.P. Antifouling properties of hydrogels. Sci. Technol. Adv. Mater. 2012, 12, 064706. [Google Scholar] [CrossRef] [Green Version]
- Damodaran, V.B.; Murthy, N.S. Bio-inspired strategies for designing antifouling biomaterials. Biomater. Res. 2016, 20, 1–11. [Google Scholar] [CrossRef] [Green Version]
- Chien, H.-W.; Chen, X.-Y.; Tsai, W.-P.; Lee, M. Inhibition of biofilm formation by rough shark skin-patterned surfaces. Colloids Surf. B Biointerfaces 2020, 186, 110738. [Google Scholar] [CrossRef]
- Kesel, A.B.; Liedert, R. Learning from nature: Non-toxic biofouling control by shark skin effect. Comp. Biochem. Physiol. A-Mol. Integr. Physiol. 2007, 146, S130. [Google Scholar] [CrossRef]
- Jaggessar, A.; Shahali, H.; Mathew, A.; Yarlagadda, P.K. Bio-mimicking nano and micro-structured surface fabrication for antibacterial properties in medical implants. J. Nanobiotechnol. 2017, 15, 1–20. [Google Scholar] [CrossRef] [PubMed] [Green Version]
- Bers, A.V.; Wahl, M. The influence of natural surface microtopographies on fouling. Biofouling 2004, 20, 43–51. [Google Scholar] [CrossRef]
- Scardino, A.; Hudleston, D.; Peng, Z.; Paul, N.A.; De Nys, R. Biomimetic characterisation of key surface parameters for the development of fouling resistant materials. Biofouling 2009, 25, 83–93. [Google Scholar] [CrossRef] [PubMed]
- Lowe, S.; O'Brien-Simpson, N.M.; Connal, L.A. Antibiofouling polymer interfaces: Poly (ethylene glycol) and other promising candidates. Polym. Chem. 2015, 6, 198–212. [Google Scholar] [CrossRef] [Green Version]
- Lei, J.; Mayer, C.; Freger, V.; Ulbricht, M. Synthesis and characterization of poly (ethylene glycol) methacrylate based hydrogel networks for anti-biofouling applications. Macromol. Mater. Eng. 2013, 298, 967–980. [Google Scholar] [CrossRef]
- Bernhard, C.; Roeters, S.J.; Franz, J.; Weidner, T.; Bonn, M.; Gonella, G. Repelling and ordering: The influence of poly (ethylene glycol) on protein adsorption. Phys. Chem. Chem. Phys. 2017, 19, 28182–28188. [Google Scholar] [CrossRef] [PubMed] [Green Version]
- Müller, R.; Eidt, A.; Hiller, K.-A.; Katzur, V.; Subat, M.; Schweikl, H.; Imazato, S.; Ruhl, S.; Schmalz, G. Influences of protein films on antibacterial or bacteria-repellent surface coatings in a model system using silicon wafers. Biomaterials 2009, 30, 4921–4929. [Google Scholar] [CrossRef]
- Yang, Y.-F.; Li, Y.; Li, Q.-L.; Wan, L.-S.; Xu, Z.-K. Surface hydrophilization of microporous polypropylene membrane by grafting zwitterionic polymer for anti-biofouling. J. Membr. Sci. 2010, 362, 255–264. [Google Scholar] [CrossRef]
- Dai, G.; Xie, Q.; Ai, X.; Ma, C.; Zhang, G. Self-generating and self-renewing zwitterionic polymer surfaces for marine anti-biofouling. ACS Appl. Mater. Interfaces 2019, 11, 41750–41757. [Google Scholar] [CrossRef]
- Privett, B.J.; Youn, J.; Hong, S.A.; Lee, J.; Han, J.; Shin, J.H.; Schoenfisch, M.H. Antibacterial fluorinated silica colloid superhydrophobic surfaces. Langmuir 2011, 27, 9597–9601. [Google Scholar] [CrossRef] [Green Version]
- Xie, Q.; Zeng, H.; Peng, Q.; Bressy, C.; Ma, C.; Zhang, G. Self-Stratifying Silicone Coating with Nonleaching Antifoulant for Marine Anti-Biofouling. Adv. Mater. Interfaces 2019, 6, 1900535. [Google Scholar] [CrossRef]
- Zheng, S.; Yang, Q.; Mi, B. Novel antifouling surface with improved hemocompatibility by immobilization of polyzwitterions onto silicon via click chemistry. Appl. Surf. Sci. 2016, 363, 619–626. [Google Scholar] [CrossRef] [Green Version]
- Andel, E.; Maarten, M. Water-repairable zwitterionic polymer coatings for anti-biofouling surfaces. J. Mater. Chem. B 2017, 5, 6728–6733. [Google Scholar]
- Wang, C.; Wang, T.; Hu, P.; Shen, T.; Xu, J.; Ding, C.; Fu, J. Dual-functional anti-biofouling coatings with intrinsic self-healing ability. Chem. Eng. J. 2020, 389, 123469. [Google Scholar] [CrossRef]
- Nguyen, A.T.; Baggerman, J.; Paulusse, J.M.; van Rijn, C.J.; Zuilhof, H. Stable protein-repellent zwitterionic polymer brushes grafted from silicon nitride. Langmuir 2011, 27, 2587–2594. [Google Scholar] [CrossRef] [PubMed]
- Barish, J.A.; Goddard, J.M. Anti-fouling surface modified stainless steel for food processing. Food Bioprod. Process. 2013, 91, 352–361. [Google Scholar] [CrossRef]
- Okada, A.; Nikaido, T.; Ikeda, M.; Okada, K.; Yamauchi, J.; Foxton, R.M.; Sawada, H.; Tagami, J.; Matin, K. Inhibition of biofilm formation using newly developed coating materials with self-cleaning properties. Dent. Mater. J. 2008, 27, 565–572. [Google Scholar] [CrossRef] [Green Version]
- Acosta, S.; Ibañez-Fonseca, A.; Aparicio, C.; Rodríguez-Cabello, J.C. Antibiofilm coatings based on protein-engineered polymers and antimicrobial peptides for preventing implant-associated infections. Biomater. Sci. 2020, 8, 2866–2877. [Google Scholar] [CrossRef] [PubMed]
- Jain, A.; Duvvuri, L.S.; Farah, S.; Beyth, N.; Domb, A.J.; Khan, W. Antimicrobial polymers. Adv. Healthc. Mater. 2014, 3, 1969–1985. [Google Scholar] [CrossRef]
- Tan, Z.; Shi, Y.; Xing, B.; Hou, Y.; Cui, J.; Jia, S. The antimicrobial effects and mechanism of ε-poly-lysine against Staphylococcus aureus. Bioresour. Bioprocess. 2019, 6, 1–11. [Google Scholar] [CrossRef]
- D’Almeida, M.; Attik, N.; Amalric, J.; Brunon, C.; Renaud, F.; Abouelleil, H.; Toury, B.; Grosgogeat, B. Chitosan coating as an antibacterial surface for biomedical applications. PLoS ONE 2017, 12, e0189537. [Google Scholar] [CrossRef] [Green Version]
- Magetsari, R.; Dewo, P.; Saputro, B.; Lanodiyu, Z. Cinnamon oil and chitosan coating on orthopaedic implant surface for prevention of Staphylococcus epidermidis biofilm formation. Malays. Orthop. J. 2014, 8, 11. [Google Scholar] [CrossRef]
- Šulek, F.; Milošev, I. Inhibitory Effects of Chitosan Coating against Biofilm Formation on Metal Implants; EUT Edizioni Università di Trieste: Trieste, Italy, 2020. [Google Scholar]
- Li, B.; Xia, X.; Guo, M.; Jiang, Y.; Li, Y.; Zhang, Z.; Liu, S.; Li, H.; Liang, C.; Wang, H. Biological and antibacterial properties of the micro-nanostructured hydroxyapatite/chitosan coating on titanium. Sci. Rep. 2019, 9, 14052. [Google Scholar] [CrossRef] [Green Version]
- Guo, J.; Qin, J.; Ren, Y.; Wang, B.; Cui, H.; Ding, Y.; Mao, H.; Yan, F. Antibacterial activity of cationic polymers: Side-chain or main-chain type? Polym. Chem. 2018, 9, 4611–4616. [Google Scholar] [CrossRef]
- Choi, H.; Chakraborty, S.; Liu, R.; Gellman, S.H.; Weisshaar, J.C. Single-cell, time-resolved antimicrobial effects of a highly cationic, random nylon-3 copolymer on live Escherichia coli. ACS Chem. Biol. 2016, 11, 113–120. [Google Scholar] [CrossRef] [PubMed] [Green Version]
- Hadjesfandiari, N.; Weinhart, M.; Kizhakkedathu, J.N.; Haag, R.; Brooks, D.E. Development of antifouling and bactericidal coatings for platelet storage bags using dopamine chemistry. Adv. Healthc. Mater. 2018, 7, 1700839. [Google Scholar] [CrossRef] [PubMed]
- Bhadury, P.; Wright, P.C. Exploitation of marine algae: Biogenic compounds for potential antifouling applications. Planta 2004, 219, 561–578. [Google Scholar] [CrossRef] [PubMed]
- Janssens, J.C.; Steenackers, H.; Robijns, S.; Gellens, E.; Levin, J.; Zhao, H.; Hermans, K.; De Coster, D.; Verhoeven, T.L.; Marchal, K. Brominated furanones inhibit biofilm formation by Salmonella enterica serovar Typhimurium. Appl. Environ. Microbiol. 2008, 74, 6639–6648. [Google Scholar] [CrossRef] [Green Version]
- Al-Bataineh, S.A.; Britcher, L.G.; Griesser, H.J. XPS characterization of the surface immobilization of antibacterial furanones. Surf. Sci. 2006, 600, 952–962. [Google Scholar] [CrossRef]
- Al-Bataineh, S.A.; Britcher, L.G.; Griesser, H.J. Rapid radiation degradation in the XPS analysis of antibacterial coatings of brominated furanones. Surf. Interface Anal. Int. J. Devoted Dev. Appl. Tech. Anal. Surf. Interfaces Thin Film. 2006, 38, 1512–1518. [Google Scholar] [CrossRef]
- Schmidmaier, G.; Lucke, M.; Wildemann, B.; Haas, N.P.; Raschke, M. Prophylaxis and treatment of implant-related infections by antibiotic-coated implants: A review. Injury 2006, 37, S105–S112. [Google Scholar] [CrossRef]
- Lucke, M.; Schmidmaier, G.; Sadoni, S.; Wildemann, B.; Schiller, R.; Haas, N.; Raschke, M. Gentamicin coating of metallic implants reduces implant-related osteomyelitis in rats. Bone 2003, 32, 521–531. [Google Scholar] [CrossRef]
- Garvin, K.L.; Miyano, J.A.; Robinson, D.; Giger, D.; Novak, J.; Radio, S. Polylactide/polyglycolide antibiotic implants in the treatment of osteomyelitis. A canine model. JBJS 1994, 76, 1500–1506. [Google Scholar] [CrossRef] [PubMed]
- Yu, X.; Liao, X.; Chen, H. Antibiotic-loaded MMT/PLL-based coating on the surface of endosseous implants to suppress bacterial infections. Int. J. Nanomed. 2021, 16, 2983. [Google Scholar] [CrossRef] [PubMed]
- Yook, J.H.; Sung, H. In vitro antibacterial efficacy of Vicryl and PDS plus antibacterial suture. J. Korean Surg. Soc. 2010, 78, 1–6. [Google Scholar] [CrossRef]
- Adkins, J.M.; Al Ahmar, R.; Hongwei, D.Y.; Musick, S.T.; Alberico, A.M. Comparison of antimicrobial activity between bacitracin-soaked sutures and triclosan coated suture. J. Surg. Res. 2022, 270, 203–207. [Google Scholar] [CrossRef] [PubMed]
- Hoshino, S.; Yoshida, Y.; Tanimura, S.; Yamauchi, Y.; Noritomi, T.; Yamashita, Y. A study of the efficacy of antibacterial sutures for surgical site infection: A retrospective controlled trial. Int. Surg. 2013, 98, 129–132. [Google Scholar] [CrossRef] [Green Version]
- Zhang, S.; Liu, X.; Wang, H.; Peng, J.; Wong, K.K. Silver nanoparticle-coated suture effectively reduces inflammation and improves mechanical strength at intestinal anastomosis in mice. J. Pediatr. Surg. 2014, 49, 606–613. [Google Scholar] [CrossRef]
- Masoud, A.-R.; Alakija, F.; Perves Bappy, M.J.; Mills, P.A.; Mills, D.K. Metallizing the Surface of Halloysite Nanotubes—A Review. Coatings 2023, 13, 542. [Google Scholar] [CrossRef]
- Su, C.; Huang, K.; Li, H.-H.; Lu, Y.-G.; Zheng, D.-L. Antibacterial properties of functionalized gold nanoparticles and their application in oral biology. J. Nanomater. 2020, 2020, 1–13. [Google Scholar] [CrossRef]
- Arakha, M.; Pal, S.; Samantarrai, D.; Panigrahi, T.K.; Mallick, B.C.; Pramanik, K.; Mallick, B.; Jha, S. Antimicrobial activity of iron oxide nanoparticle upon modulation of nanoparticle-bacteria interface. Sci. Rep. 2015, 5, 14813. [Google Scholar] [CrossRef] [Green Version]
- Elsaka, S.E.; Hamouda, I.M.; Swain, M.V. Titanium dioxide nanoparticles addition to a conventional glass-ionomer restorative: Influence on physical and antibacterial properties. J. Dent. 2011, 39, 589–598. [Google Scholar] [CrossRef] [PubMed]
- Sirelkhatim, A.; Mahmud, S.; Seeni, A.; Kaus, N.H.M.; Ann, L.C.; Bakhori, S.K.M.; Hasan, H.; Mohamad, D. Review on zinc oxide nanoparticles: Antibacterial activity and toxicity mechanism. Nano-Micro Lett. 2015, 7, 219–242. [Google Scholar] [CrossRef] [PubMed] [Green Version]
- Raffi, M.; Mehrwan, S.; Bhatti, T.M.; Akhter, J.I.; Hameed, A.; Yawar, W. Investigations into the antibacterial behavior of copper nanoparticles against Escherichia coli. Ann. Microbiol. 2010, 60, 75–80. [Google Scholar] [CrossRef]
- Gao, W.; Zhang, L. Nanomaterials arising amid antibiotic resistance. Nat. Rev. Microbiol. 2021, 19, 5–6. [Google Scholar] [CrossRef] [PubMed]
- Rosenberg, M.; Visnapuu, M.; Vija, H.; Kisand, V.; Kasemets, K.; Kahru, A.; Ivask, A. Selective antibiofilm properties and biocompatibility of nano-ZnO and nano-ZnO/Ag coated surfaces. Sci. Rep. 2020, 10, 13478. [Google Scholar] [CrossRef]
- Mpenyana-Monyatsi, L.; Mthombeni, N.H.; Onyango, M.S.; Momba, M.N. Cost-effective filter materials coated with silver nanoparticles for the removal of pathogenic bacteria in groundwater. Int. J. Environ. Res. Public Health 2012, 9, 244–271. [Google Scholar] [CrossRef]
- Applerot, G.; Lellouche, J.; Perkas, N.; Nitzan, Y.; Gedanken, A.; Banin, E. ZnO nanoparticle-coated surfaces inhibit bacterial biofilm formation and increase antibiotic susceptibility. Rsc Adv. 2012, 2, 2314–2321. [Google Scholar] [CrossRef]
- Yilmaz Atay, H.; Yaşa, İ.; Çelik, E. Antibacterial polymeric coatings with synthesized silver nanoparticles. Synth. React. Inorg. Met. -Org. Nano-Met. Chem. 2015, 45, 784–798. [Google Scholar] [CrossRef]
- Ghule, K.; Ghule, A.V.; Chen, B.-J.; Ling, Y.-C. Preparation and characterization of ZnO nanoparticles coated paper and its antibacterial activity study. Green Chem. 2006, 8, 1034–1041. [Google Scholar] [CrossRef] [Green Version]
- Zhao, L.; Wang, H.; Huo, K.; Cui, L.; Zhang, W.; Ni, H.; Zhang, Y.; Wu, Z.; Chu, P.K. Antibacterial nano-structured titania coating incorporated with silver nanoparticles. Biomaterials 2011, 32, 5706–5716. [Google Scholar] [CrossRef]
- Cabal, B.; Cafini, F.; Esteban-Tejeda, L.; Alou, L.; Bartolomé, J.F.; Sevillano, D.; López-Piriz, R.; Torrecillas, R.; Moya, J.S. Inhibitory effect on in vitro Streptococcus oralis biofilm of a soda-lime glass containing silver nanoparticles coating on titanium alloy. PLoS ONE 2012, 7, e42393. [Google Scholar] [CrossRef] [Green Version]
- Secinti, K.D.; Özalp, H.; Attar, A.; Sargon, M.F. Nanoparticle silver ion coatings inhibit biofilm formation on titanium implants. J. Clin. Neurosci. 2011, 18, 391–395. [Google Scholar] [CrossRef] [PubMed]
- Liu, C.; Yao, W.; Tian, M.; Wei, J.; Song, Q.; Qiao, W. Mussel-inspired degradable antibacterial polydopamine/silica nanoparticle for rapid hemostasis. Biomaterials 2018, 179, 83–95. [Google Scholar] [CrossRef] [PubMed]
- Dizaj, S.M.; Mennati, A.; Jafari, S.; Khezri, K.; Adibkia, K. Antimicrobial activity of carbon-based nanoparticles. Adv. Pharm. Bull. 2015, 5, 19. [Google Scholar]
- Oh, E.J.; Oh, S.H.; Lee, I.S.; Kwon, O.S.; Lee, J.H. Antibiotic-eluting hydrophilized PMMA bone cement with prolonged bactericidal effect for the treatment of osteomyelitis. J. Biomater. Appl. 2016, 30, 1534–1544. [Google Scholar] [CrossRef] [PubMed]
- Mistry, S.; Burman, S.; Roy, S.; Maitra, N.J.; Roy, R.; Chanda, A. Biological analysis of an innovative biodegradable antibiotic eluting bioactive glass/gypsum composite bone cement for treating experimental chronic MRSA osteomyelitis. J. Pharm. Anal. 2022, 12, 164–177. [Google Scholar] [CrossRef] [PubMed]
- Scott, C.P.; Higham, P.A. Antibiotic bone cement for the treatment of pseudomonas aeruginosa in joint arthroplasty: Comparison of tobramycin and gentamicin-loaded cements. J. Biomed. Mater. Res. Part B Appl. Biomater. 2003, 64, 94–98. [Google Scholar] [CrossRef]
- Lipsky, B.A.; Hoey, C. Topical antimicrobial therapy for treating chronic wounds. Clin. Infect. Dis. 2009, 49, 1541–1549. [Google Scholar] [CrossRef] [Green Version]
- Elsner, J.J.; Zilberman, M. Novel antibiotic-eluting wound dressings: An in vitro study and engineering aspects in the dressing’s design. J. Tissue Viability 2010, 19, 54–66. [Google Scholar] [CrossRef]
- Shefy-Peleg, A.; Foox, M.; Cohen, B.; Zilberman, M. Novel antibiotic-eluting gelatin-alginate soft tissue adhesives for various wound closing applications. Int. J. Polym. Mater. Polym. Biomater. 2014, 63, 699–707. [Google Scholar] [CrossRef]
- Jatoi, A.W. Polyurethane nanofibers incorporated with ZnAg composite nanoparticles for antibacterial wound dressing applications. Compos. Commun. 2020, 19, 103–107. [Google Scholar] [CrossRef]
- Jang, J.; Lee, J.-M.; Oh, S.-B.; Choi, Y.; Jung, H.-S.; Choi, J. Development of antibiofilm nanocomposites: Ag/Cu bimetallic nanoparticles synthesized on the surface of graphene oxide nanosheets. ACS Appl. Mater. Interfaces 2020, 12, 35826–35834. [Google Scholar] [CrossRef]
- Unnithan, A.R.; Barakat, N.A.; Pichiah, P.T.; Gnanasekaran, G.; Nirmala, R.; Cha, Y.-S.; Jung, C.-H.; El-Newehy, M.; Kim, H.Y. Wound-dressing materials with antibacterial activity from electrospun polyurethane–dextran nanofiber mats containing ciprofloxacin HCl. Carbohydr. Polym. 2012, 90, 1786–1793. [Google Scholar] [CrossRef]
- Jannesari, M.; Varshosaz, J.; Morshed, M.; Zamani, M. Composite poly (vinyl alcohol)/poly (vinyl acetate) electrospun nanofibrous mats as a novel wound dressing matrix for controlled release of drugs. Int. J. Nanomed. 2011, 6, 993–1003. [Google Scholar]
- El-Shanshory, A.; Chen, W.-M.; Mo, X.-M. Preparation of antibacterial electrospun PVA/regenerated silk fibroin nanofibrous composite containing ciprofloxacin hydrochloride as a wound dressing. J. Donghua Univ. Eng. Ed. Vol 2014, 31, 556–571. [Google Scholar]
- Öztürk, E.; Ağalar, C.; Keçeci, K.; Denkbas, E.B. Preparation and characterization of ciprofloxacin-loaded alginate/chitosan sponge as a wound dressing material. J. Appl. Polym. Sci. 2006, 101, 1602–1609. [Google Scholar] [CrossRef]
- Tsou, T.-L.; Tang, S.-T.; Huang, Y.-C.; Wu, J.-R.; Young, J.-J.; Wang, H.-J. Poly (2-hydroxyethyl methacrylate) wound dressing containing ciprofloxacin and its drug release studies. J. Mater. Sci. Mater. Med. 2005, 16, 95–100. [Google Scholar] [CrossRef]
- Sinha, M.; Banik, R.M.; Haldar, C.; Maiti, P. Development of ciprofloxacin hydrochloride loaded poly (ethylene glycol)/chitosan scaffold as wound dressing. J. Porous Mater. 2013, 20, 799–807. [Google Scholar] [CrossRef]
- Kota, S.; Jahangir, M.A.; Ahmed, M.; Kazmi, I.; Bhavani, P.; Muheem, A.; Saleem, M. Development and evaluation of ofloxacin topical gel containing wound healing modifiers from natural sources. Der Pharm. Lett 2015, 7, 226–233. [Google Scholar]
- Chen, X.; Li, H.; Qiao, X.; Jiang, T.; Fu, X.; He, Y.; Zhao, X. Agarose oligosaccharide-silver nanoparticle-antimicrobial peptide-composite for wound dressing. Carbohydr. Polym. 2021, 269, 118258. [Google Scholar] [CrossRef] [PubMed]
- Chen, H.; Lan, G.; Ran, L.; Xiao, Y.; Yu, K.; Lu, B.; Dai, F.; Wu, D.; Lu, F. A novel wound dressing based on a Konjac glucomannan/silver nanoparticle composite sponge effectively kills bacteria and accelerates wound healing. Carbohydr. Polym. 2018, 183, 70–80. [Google Scholar] [CrossRef]
- Kalaoglu-Altan, O.I.; Baskan, H.; Meireman, T.; Basnett, P.; Azimi, B.; Fusco, A.; Funel, N.; Donnarumma, G.; Lazzeri, A.; Roy, I. Silver nanoparticle-coated polyhydroxyalkanoate based electrospun fibers for wound dressing applications. Materials 2021, 14, 4907. [Google Scholar] [CrossRef] [PubMed]
- Shi, Y.; Truong, V.X.; Kulkarni, K.; Qu, Y.; Simon, G.P.; Boyd, R.L.; Perlmutter, P.; Lithgow, T.; Forsythe, J.S. Light-triggered release of ciprofloxacin from an in situ forming click hydrogel for antibacterial wound dressings. J. Mater. Chem. B 2015, 3, 8771–8774. [Google Scholar] [CrossRef] [PubMed]
- Khundkar, R.; Malic, C.; Burge, T. Use of Acticoat™ dressings in burns: What is the evidence? Burns 2010, 36, 751–758. [Google Scholar] [CrossRef]
- Erring, M.; Gaba, S.; Mohsina, S.; Tripathy, S.; Sharma, R.K. Comparison of efficacy of silver-nanoparticle gel, nano-silver-foam and collagen dressings in treatment of partial thickness burn wounds. Burns 2019, 45, 1888–1894. [Google Scholar] [CrossRef] [PubMed]
- Jiji, S.; Udhayakumar, S.; Maharajan, K.; Rose, C.; Muralidharan, C.; Kadirvelu, K. Bacterial cellulose matrix with in situ impregnation of silver nanoparticles via catecholic redox chemistry for third degree burn wound healing. Carbohydr. Polym. 2020, 245, 116573. [Google Scholar] [CrossRef]
- Nuutila, K.; Grolman, J.; Yang, L.; Broomhead, M.; Lipsitz, S.; Onderdonk, A.; Mooney, D.; Eriksson, E. Immediate treatment of burn wounds with high concentrations of topical antibiotics in an alginate hydrogel using a platform wound device. Adv. Wound Care 2020, 9, 48–60. [Google Scholar] [CrossRef]
- Song, J.; Zhang, P.; Cheng, L.; Liao, Y.; Xu, B.; Bao, R.; Wang, W.; Liu, W. Nano-silver in situ hybridized collagen scaffolds for regeneration of infected full-thickness burn skin. J. Mater. Chem. B 2015, 3, 4231–4241. [Google Scholar] [CrossRef]
- Masood, N.; Ahmed, R.; Tariq, M.; Ahmed, Z.; Masoud, M.S.; Ali, I.; Asghar, R.; Andleeb, A.; Hasan, A. Silver nanoparticle impregnated chitosan-PEG hydrogel enhances wound healing in diabetes induced rabbits. Int. J. Pharm. 2019, 559, 23–36. [Google Scholar] [CrossRef]
- Kuwabara, M.; Sato, Y.; Ishihara, M.; Takayama, T.; Nakamura, S.; Fukuda, K.; Murakami, K.; Yokoe, H.; Kiyosawa, T. Healing of Pseudomonas aeruginosa-infected wounds in diabetic db/db mice by weakly acidic hypochlorous acid cleansing and silver nanoparticle/chitin-nanofiber sheet covering. Wound Med. 2020, 28, 100183. [Google Scholar] [CrossRef]
- Almonaci Hernández, C.; Juarez-Moreno, K.; Castañeda-Juarez, M.; Almanza-Reyes, H.; Pestryakov, A.; Bogdanchikova, N. Silver nanoparticles for the rapid healing of diabetic foot ulcers. Int. J. Med. Nano Res 2017, 4, 2378–3664. [Google Scholar]
- Hu, S.; Cai, X.; Qu, X.; Yu, B.; Yan, C.; Yang, J.; Li, F.; Zheng, Y.; Shi, X. Preparation of biocompatible wound dressings with long-term antimicrobial activity through covalent bonding of antibiotic agents to natural polymers. Int. J. Biol. Macromol. 2019, 123, 1320–1330. [Google Scholar] [CrossRef]
- Bakhsheshi-Rad, H.R.; Hadisi, Z.; Ismail, A.F.; Aziz, M.; Akbari, M.; Berto, F.; Chen, X. In vitro and in vivo evaluation of chitosan-alginate/gentamicin wound dressing nanofibrous with high antibacterial performance. Polym. Test. 2020, 82, 106298. [Google Scholar] [CrossRef]
- Dwivedi, C.; Pandey, I.; Pandey, H.; Patil, S.; Mishra, S.B.; Pandey, A.C.; Zamboni, P.; Ramteke, P.W.; Singh, A.V. In vivo diabetic wound healing with nanofibrous scaffolds modified with gentamicin and recombinant human epidermal growth factor. J. Biomed. Mater. Res. Part A 2018, 106, 641–651. [Google Scholar] [CrossRef]
- Ahmed, R.; Tariq, M.; Ali, I.; Asghar, R.; Khanam, P.N.; Augustine, R.; Hasan, A. Novel electrospun chitosan/polyvinyl alcohol/zinc oxide nanofibrous mats with antibacterial and antioxidant properties for diabetic wound healing. Int. J. Biol. Macromol. 2018, 120, 385–393. [Google Scholar] [CrossRef] [PubMed]
- Wang, T.; Zheng, Y.; Shi, Y.; Zhao, L. pH-responsive calcium alginate hydrogel laden with protamine nanoparticles and hyaluronan oligosaccharide promotes diabetic wound healing by enhancing angiogenesis and antibacterial activity. Drug Deliv. Transl. Res. 2019, 9, 227–239. [Google Scholar] [CrossRef]
- You, C.; Li, Q.; Wang, X.; Wu, P.; Ho, J.K.; Jin, R.; Zhang, L.; Shao, H.; Han, C. Silver nanoparticle loaded collagen/chitosan scaffolds promote wound healing via regulating fibroblast migration and macrophage activation. Sci. Rep. 2017, 7, 10489. [Google Scholar] [CrossRef] [PubMed] [Green Version]
- Khorasani, M.T.; Joorabloo, A.; Adeli, H.; Milan, P.B.; Amoupour, M. Enhanced antimicrobial and full-thickness wound healing efficiency of hydrogels loaded with heparinized ZnO nanoparticles: In vitro and in vivo evaluation. Int. J. Biol. Macromol. 2021, 166, 200–212. [Google Scholar] [CrossRef]
- Melaiye, A.; Youngs, W.J. Silver and Its Application as an Antimicrobial Agent; Taylor & Francis: Milton Park, UK, 2005; Volume 15, pp. 125–130. [Google Scholar]
- Wong, M.-S.; Chen, C.-W.; Hsieh, C.-C.; Hung, S.-C.; Sun, D.-S.; Chang, H.-H. Antibacterial property of Ag nanoparticle-impregnated N-doped titania films under visible light. Sci. Rep. 2015, 5, 11978. [Google Scholar] [CrossRef] [Green Version]
- Dakal, T.C.; Kumar, A.; Majumdar, R.S.; Yadav, V. Mechanistic basis of antimicrobial actions of silver nanoparticles. Front. Microbiol. 2016, 7, 1831. [Google Scholar] [CrossRef] [PubMed] [Green Version]
- Martínez-Castañon, G.-A.; Nino-Martinez, N.; Martinez-Gutierrez, F.; Martínez-Mendoza, J.; Ruiz, F. Synthesis and antibacterial activity of silver nanoparticles with different sizes. J. Nanopart. Res. 2008, 10, 1343–1348. [Google Scholar] [CrossRef]
- Abbaszadegan, A.; Ghahramani, Y.; Gholami, A.; Hemmateenejad, B.; Dorostkar, S.; Nabavizadeh, M.; Sharghi, H. The effect of charge at the surface of silver nanoparticles on antimicrobial activity against gram-positive and gram-negative bacteria: A preliminary study. J. Nanomater. 2015, 16, 53. [Google Scholar] [CrossRef] [Green Version]
- Pal, S.; Tak, Y.K.; Song, J.M. Does the antibacterial activity of silver nanoparticles depend on the shape of the nanoparticle? A study of the gram-negative bacterium Escherichia coli. Appl. Environ. Microbiol. 2007, 73, 1712–1720. [Google Scholar] [CrossRef] [PubMed] [Green Version]
- Sánchez-López, E.; Gomes, D.; Esteruelas, G.; Bonilla, L.; Lopez-Machado, A.L.; Galindo, R.; Cano, A.; Espina, M.; Ettcheto, M.; Camins, A. Metal-based nanoparticles as antimicrobial agents: An overview. Nanomaterials 2020, 10, 292. [Google Scholar] [CrossRef] [PubMed] [Green Version]
- Lewinski, N.; Colvin, V.; Drezek, R. Cytotoxicity of nanoparticles. Small 2008, 4, 26–49. [Google Scholar] [CrossRef]
- Ngashangva, L.; Hemdan, B.A.; El-Liethy, M.A.; Bachu, V.; Minteer, S.D.; Goswami, P. Emerging bioanalytical devices and platforms for rapid detection of pathogens in environmental samples. Micromachines 2022, 13, 1083. [Google Scholar] [CrossRef]
- Castillo-Henríquez, L.; Brenes-Acuña, M.; Castro-Rojas, A.; Cordero-Salmerón, R.; Lopretti-Correa, M.; Vega-Baudrit, J.R. Biosensors for the detection of bacterial and viral clinical pathogens. Sensors 2020, 20, 6926. [Google Scholar] [CrossRef]
- Miethke, M.; Pieroni, M.; Weber, T.; Brönstrup, M.; Hammann, P.; Halby, L.; Arimondo, P.B.; Glaser, P.; Aigle, B.; Bode, H.B. Towards the sustainable discovery and development of new antibiotics. Nat. Rev. Chem. 2021, 5, 726–749. [Google Scholar] [CrossRef]
- Breijyeh, Z.; Karaman, R. Design and Synthesis of Novel Antimicrobial Agents. Antibiotics 2023, 12, 628. [Google Scholar] [CrossRef]
- Abbasi, R.; Shineh, G.; Mobaraki, M.; Doughty, S.; Tayebi, L. Structural parameters of nanoparticles affecting their toxicity for biomedical applications: A review. J. Nanopart. Res. 2023, 25, 43. [Google Scholar] [CrossRef]
- Ma, R.; Hu, X.; Zhang, X.; Wang, W.; Sun, J.; Su, Z.; Zhu, C. Strategies to prevent, curb and eliminate biofilm formation based on the characteristics of various periods in one biofilm life cycle. Front. Cell. Infect. Microbiol. 2022, 12, 1279. [Google Scholar] [CrossRef] [PubMed]
- Cámara, M.; Green, W.; MacPhee, C.E.; Rakowska, P.D.; Raval, R.; Richardson, M.C.; Slater-Jefferies, J.; Steventon, K.; Webb, J.S. Economic significance of biofilms: A multidisciplinary and cross-sectoral challenge. npj Biofilms Microbiomes 2022, 8, 42. [Google Scholar] [CrossRef] [PubMed]
- Panebianco, F.; Rubiola, S.; Di Ciccio, P.A. The use of ozone as an eco-friendly strategy against microbial biofilm in dairy manufacturing plants: A review. Microorganisms 2022, 10, 162. [Google Scholar] [CrossRef] [PubMed]

| Active Ingredients | Advantages | Disadvantages | Performance |
|---|---|---|---|
| Sodium hypochlorite, | Very good shelf life. Can be stored at room temperature. Can be a good option for household use. Additionally, it is completely safe for human hygiene [159]. | Efficacy may be reduced in the presence of organic matter [160]. | Best |
| Peroxides | Not harmful for environment [161]. Usable both in liquid and vapor form [162]. Degradable into water [161]. | It is difficult to store [162]. Sometimes its efficacy varies with the method of application [161]. | |
| chlorine dioxide gas | Zero cytotoxicity. High efficacy against biofilms [163]. | High production cost [163]. | |
| Hypochlorous acid | Low production cost. Nontoxic [164]. Safe for human hygiene. It is also effective for a wide range of viruses [163]. | High consumption is required for reduced oxidative effect [163]. | |
| Polyhexamethylene Biguanides | Soluble in water and has a very stable pH level. Nontoxic and effective for many common antimicrobials [165]. | Efficacy may change with the temperature [166]. | |
| Quaternary Ammonium Compounds | Low production cost. Almost zero toxicity [167]. | Efficacy changes with temperature. Low efficacy against biofilms [168]. | |
| Ozone (gas) | Easy to produce. Can be used in hard-to-reach places [169]. | Toxicity increases with concentration [170]. | Worst |
| Wound Type | Wound Dressing or Antimicrobial Agent | Outcome of Their Application | Reference |
|---|---|---|---|
| Burn wounds | Cticoat™ as nanocrystalline silver dressing | Better antimicrobial activity compared to another available silver dressings, reducing healing times, ease of application and low frequency of change. | [270] |
| Silver-NP gel, and nanosilver-foam | In comparison to silver NPs gel, nanosilver-foam dressings were found to be less efficacious for epithelialization, healing, and ease of application. | [271] | |
| Bacterial cellulose (BC) based nanocomposite dressing material within situ impregnation of silver NPs | Significant antimicrobial activity against burn-wound-specific pathogens. Supporting cell proliferation, promoting re-epithelization, and collagen deposition, regulating the expression of inflammatory, angiogenesis and growth factor genes. | [272] | |
| Alginate hydrogel containing vancomycin, gentamicin, and minocycline | Reducing the depth of tissue necrosis in comparison to controls and treating burn infections. | [273] | |
| Nano hybrid scaffold containing silver NPs | Silver NP hybrid scaffolds exhibited antibacterial properties against both Gram-positive and negative bacteria in the infected full-thickness burn skin of the SD rat model with excellent regeneration after three weeks. | [274] | |
| Chronic diabetic wounds | Silver NP impregnated chitosan-PEG hydrogel | Improved antimicrobial, antioxidant, and wound healing results. | [275] |
| Chitin-nanofibre sheet (CNFS)-immobilized silver NPs (CNFS/Ag NPs) by a combination of cleansing with weakly acidic hypochlorous acid | Significantly advanced granulation tissue and capillary formations wounds in db/db diabetic mice. Enhancement of wound healing and a reduction in bacteria counts. | [276] | |
| Silver NPs solution with daily topical administration (concentration of 1.8 mg/mL) | Significant improvement in the evolution of ulcers The edges of the lesion reached the point of closure. | [277] | |
| Wound dressings incorporated with antibiotic agents, ciprofloxacin HCL (CIP) and gentamicin sulphate (GS) | Prolonged antimicrobial activity Promoting wound healing by re-epithelialization, collagen deposition, and angiogenesis. | [278] | |
| Chitosan-alginate/gentamicin wound dressing nanofibrous | Enhanced skin regeneration, stimulating the formation of a thicker dermis, increasing the formation of new blood vessels, and increasing collagen deposition. | [279] | |
| Nanofibrous scaffolds modified with gentamicin and recombinant human epidermal growth factor | Induced faster wound healing activity in dorsal wounds. Effectively helpful in healing diabetic wounds. The presence of zinc oxide NPs provides a high antioxidant and antibacterial potential against E. coli, P. aeruginosa, B. subtilis and S. aureus. | [280] | |
| Chitosan/polyvinyl alcohol/zinc oxide NP mats | Protamine NPs provide strong bactericidal behaviour and reduced bacterial-induced chronic inflammation at diabetic wounds, enhanced expression of vascular endothelial growth factor. | [281] | |
| Drug- and protamine NP-loaded pH-responsive calcium alginate hydrogel | Wound healing in diabetic wounds. | [282] | |
| Full-thickness skin defects | Silver NP-loaded collagen/chitosan scaffolds | Promoting wound healing by regulating macrophage activation and fibroblast migration and providing similar structure to normal skin on day 60 post transplantation of ultra-thin skin graft. | [283] |
| Hydrogels loaded with heparinised zinc oxide NPs | Not only the mechanical strength increased up to twice by adding NPs, but also protein adsorption increased. Wound closure accelerated by heparinised zinc oxide NPs. | [284] |
Disclaimer/Publisher’s Note: The statements, opinions and data contained in all publications are solely those of the individual author(s) and contributor(s) and not of MDPI and/or the editor(s). MDPI and/or the editor(s) disclaim responsibility for any injury to people or property resulting from any ideas, methods, instructions or products referred to in the content. |
© 2023 by the authors. Licensee MDPI, Basel, Switzerland. This article is an open access article distributed under the terms and conditions of the Creative Commons Attribution (CC BY) license (https://creativecommons.org/licenses/by/4.0/).
Share and Cite
Shineh, G.; Mobaraki, M.; Perves Bappy, M.J.; Mills, D.K. Biofilm Formation, and Related Impacts on Healthcare, Food Processing and Packaging, Industrial Manufacturing, Marine Industries, and Sanitation–A Review. Appl. Microbiol. 2023, 3, 629-665. https://doi.org/10.3390/applmicrobiol3030044
Shineh G, Mobaraki M, Perves Bappy MJ, Mills DK. Biofilm Formation, and Related Impacts on Healthcare, Food Processing and Packaging, Industrial Manufacturing, Marine Industries, and Sanitation–A Review. Applied Microbiology. 2023; 3(3):629-665. https://doi.org/10.3390/applmicrobiol3030044
Chicago/Turabian StyleShineh, Ghazal, Mohammadmahdi Mobaraki, Mohammad Jabed Perves Bappy, and David K. Mills. 2023. "Biofilm Formation, and Related Impacts on Healthcare, Food Processing and Packaging, Industrial Manufacturing, Marine Industries, and Sanitation–A Review" Applied Microbiology 3, no. 3: 629-665. https://doi.org/10.3390/applmicrobiol3030044
APA StyleShineh, G., Mobaraki, M., Perves Bappy, M. J., & Mills, D. K. (2023). Biofilm Formation, and Related Impacts on Healthcare, Food Processing and Packaging, Industrial Manufacturing, Marine Industries, and Sanitation–A Review. Applied Microbiology, 3(3), 629-665. https://doi.org/10.3390/applmicrobiol3030044








